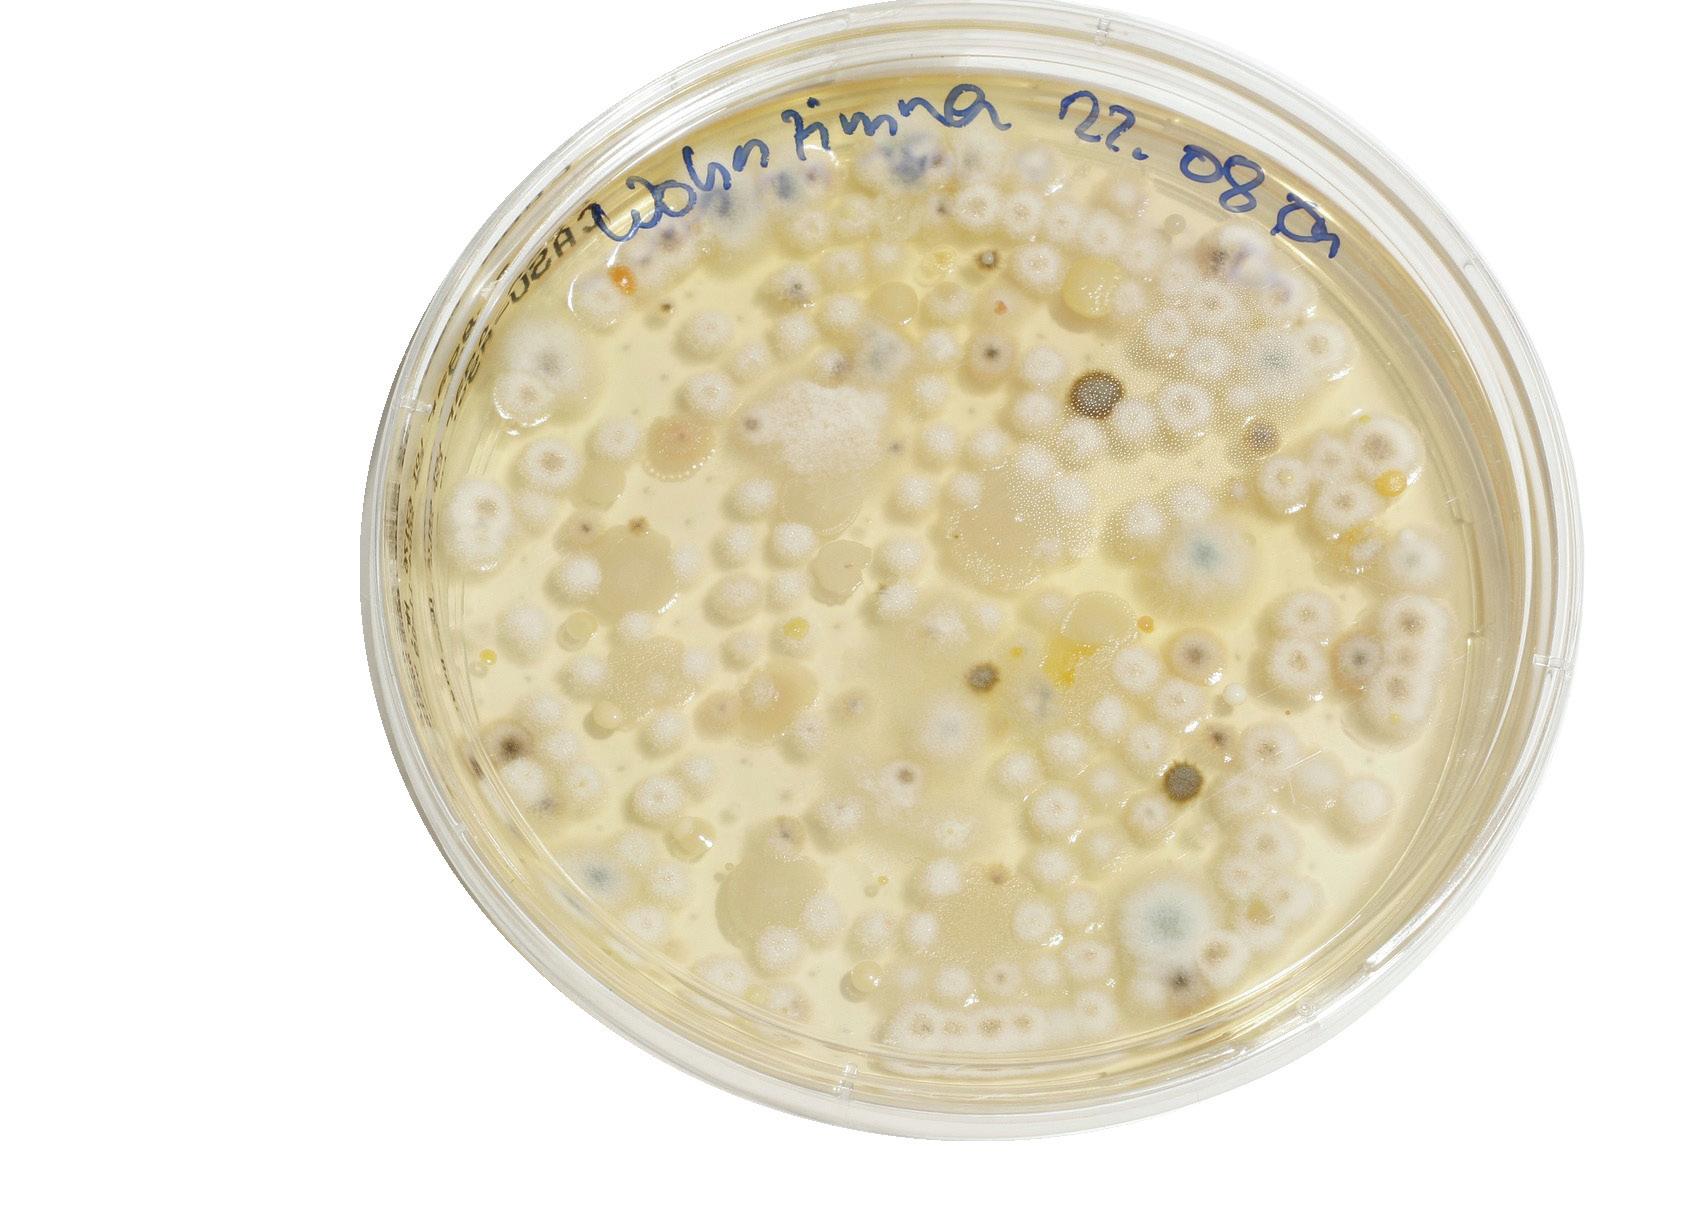

Manifestos face interrogation at annual Student Election Debates



Aseries of debates have taken place over the course of last week for NUSU’s Sabbatical Officer roles, taking place in the Students’ Union and broadcasted live on NUTV. These debates allow for candidates to break down and fully explain their manifestos ahead of the elections which are due to begin on the 6th March.
Key points raised in all the debates last week concerned the cost of living crisis as well as student wellbeing, accessibility and inclusivity. The first set of debates, taking place on Monday 27th February, included four candidates for Education Officer and three for Postgraduate Officer. Education Officer candidates Asad Qaayum, Cerys Bodey and Chloe Henderson were notably questioned on how they planned to address teaching disruption caused by the ongoing industrial action, with all three pledging to work with staff and students to ensure that all students can get the most out of teaching despite the disruption. Candidates also expanded
on their individual manifestos, with Cerys advocating for improvements to the current PEC system and 9-5 lectures for UGs to accommodate to the cost of living crisis; Chloe wanting to implement a two day gap between assessment deadlines, as well as reform for the PEC and Student Support Plan system; and Asad emphasising the importance of collaboration with other Sabbatical Officers, students and the university.


Postgraduate Officer candidates Chirag Kumar, Rishabh Toliya and Stephen Affiru were asked to elaborate on their manifestos after an audience question noticed that there was little mention of postgraduate research students in their manifestos. All three candidates reiterated their desire to work with postgraduate students to make the most out of their education. In their individual manifestoes, Chirag pledges to make mental health a priority, as well as accessibility across campus, Rishabh aims to provide postgraduate students with skills and knowledge necessary to further their careers outside of university and Stephen plans to collaborate with other Sabbatical Officers as well as students to address challenges faced by
postgraduate students.


Tuesday 28th February saw debates for the Welfare and Equality Officer and Athletic Union. Welfare and Equality Officer candidates include Lucy Leeds, Anirban Debnath, Azra Anver, Pooja Aravindakumar, Pratishtha Verma and Tanvi Sharma, however Pratishtha Verma was not present at the debate. Key focuses for this debate included mental health, the cost of living crisis and sexual assault awareness. Lucy, whilst referring to her experience as President of the Feminist Society, cites ‘the three- Cs’ in her manifesto: clarity, cost of living and community whilst advocating for further support for sexual assault victims. Anirban places heavy emphasis on creating safe spaces in order to destigmatize conversations surrounding mental health. Azra aims to help all students feel represented and comfortable enough to seek help when necessary. Pooja took a different approach to her manifesto, referring to her personal experiences of moving abroad to Newcastle and settling to complete her studies, in hopes that her message would resonate with her fellow students. Most notably, Tanvi pledged to start dental and eye-checks, something that has typically been overlooked by
the university. Only one candidate, Kimiko Cheng is currently running for Athletics Union Officer. Having had experience as a member of the Water Polo club and intramural netball, Kimiko focuses on supporting newer people with an interest in sports and intramural teams, and particularly aims to start a disability sports club, making sport more accessible to students.
Thursday 2nd March oversaw the debates for Student Media Officer and Activities Officer. The debates for Student Media Officer was evidently sought after, with a full audience observing Gabbi de Boer, Castor Chan, Roby Mukherji and Rowan Driver breaking down their manifestos. All questions had a heavy focus on uniting all three branches of Student Media and creating more job opportunities for those wanting to enter the media industry. All candidates pledged to increase funding for NUTV and NSR in order for them to reach their full potential. In terms of the candidates key manifesto points, Rowan has expressed her desire to create a fourth branch of student for photography and artistic media, Gabbi aims to create levels to software training, Roby expressed
his desire to make the roles of Station Manager of NSR and NUTV paid roles and Castor aims to establish a middle ground between all branches of Student Media to ensure they all receive the same amount of support.

Activities Officer candidates included Jade Wang, Alex Theodosiou, Ethan Graham, Yanan Zhang, Dan Paston and Yancy Zhang. Issues concerning accessibility and wellbeing amongst all students were raised in these series of debates. Candidates mentioned in their manifestos their desire to improve wellbeing services within societies to ensure a comfortable experience for students. Many of the candidates also expressed their desire to act as a liaison for societies that wish to collaborate.
The final debate to take place on Friday 3rd March was the Presidential debates, with candidates including Anuraag Roy, Rajnish Lochab, Shah Yaseen Ali and Abjol Miah. All candidates were made to address topics such as the ongoing strike action and spiking, both of which have been serious issues students have faced over the last couple of years. Shah expanded on his manifesto point of free iPads for all students, explaining that it is not his top priority compared to issues such as the cost of living crisis but believes that it can enhance the student experience and accessibility. Abjol pledged to create more jobs by bringing in third year undergraduate and postgraduate students to help students affected by strike action get the most out of their education. Anuraag mentioned in the debate that he wanted to create a culture of transparency, in which victims of sexual harassment and assault can come forward without shame. Rajnish emphasised the importance of creating an atmosphere in which students can live their lives at university to their fullest potential. With debate week coming to an end, all Newcastle University students will be able to access all candidates manifestos on the NUSU website. Voting will commence on 6th March at 1PM and close at 2PM on 9th March. Be sure to read all the manifestos and cast your vote!
Issue 1441 Monday 6th March 2023
Free every week
Est. 1948
| page 28
thecourieronline.co.uk Celebrating 75 years as Newcastle’s official student newspaper Some simple, yet effective, ways to wind down In honour of International Women’s Day, we take a moment to celebrate the dedication of women behind the camera Let’s celebrate female directors! A strikes specter! Has enough been done to mitigate the disruption of strikes? A little self care, please
Samantha Seidu - Fashion & Beauty sub-editor
Film
Lifestyle | page 17
Campus Comment | page 9 Images: Autumn-Lily Keil
A note from the Editor
What a week! Student Media successfully produced 7 debates for the Sabbatical Officer candidates last week. These debates are a cornerstone of the annual work of Student Media, with all branches pulling their weight to get this project off the ground. In my three years involved in this project, I have to say that the debates of 2023 are the best I have been a part of. We prioritised welfare and accessibility, and I think that’s the reason that we had such fantastic engagement from both candidates and the wider student body.
I am so grateful to everyone involved in this project; to the students who volunteered with us for the first time in roles such as presenters, moderators, and camera operators, to the candidates for taking the time out of their day to chat more about their manifestos, and to NUSU for helping to promote the event.
However, there are some specific thank yous that I need to give. Thank you to Rachel Carron and Autumn Keil for being my right-hand women for the entirety of this week. It’s been a pleasure to watch the two of you step up, organise others and demonstrate your
Inside 6th March 2023
Current Affairs | Opinion
A retrospective on Jimmy Carter
We reflect back on the life of 39th President, and Nobel Peace Prize winner, Carter as he nears the end of his life | Page 11
Current Affairs | Science
The Last of Us: Humanity's threat of fungi
With approximately 12 million species of fungi out there, we may well have a ticking time bomb on our hands... | Page 13
Life & Style | Lifestyle
Why lending money is risky
Loved ones may overstep boundaries and time limits on your money lending, dropping you in a financial feud | Page 17
Life & Style | Travel
Most scenic train rides in Europe
From Switzerland's Bernina Express to the UK's Caledonian Sleeper, which rail will be your next go-to? | Page 24
Culture | Music
Live Review: Loyle Carner
Sentiment and care swept the stage as Carner's melodic verses aim to heal or help one fan at a time | Page 25
Culture | Arts
Roald Dahl censoring controversy
Vast editing and censoring of Dahl's works have been carried out in a bid to establish inoffensive and accessible text | Page 30
creativity and leadership abilities. The second thank you goes to NUTV. Thank you to Sophie Mcmillan and Daisy Harrison for providing the setup and ability to livestream these debates. The two of you are a fantastic team, and NUTV has been lucky enough to be led by you this year. I’d also like to thank Katie Siddall for taking the time to interview each Liberation Officer candidate for NSR. These interviews turned out so well; you are honestly an indispensable asset to Student Media. Finally, I’d like to thank James Turner - the man, the myth, the bloody legend. I could write an entire note
about how incredible I think this man is, but I’ll try to keep this short. Thanks to James for aiding with the production of sound this week. Whilst just being around you stresses me out just a little (to put it nicely - wink wink), hearing you ask each candidate what they ate for breakfast never gets old!
I just want to reiterate how much of an honour it is to work with so many fantastic students. Your talent, passion and hard work make my job as easy as it can be, and for that, I will forever be grateful. Being able to watch you all flourish in roles that truly demonstrate
THE COURIER SECTIONS
Editor-in-Chief Meg Howe (she/her) -- mediaofficer.union@newcastle.ac.uk
Current Affairs
Senior editor: Elsa Tarring (she/her) -- e.tarring1@ncl.ac.uk


News
Poppy Bedford
Alice Holmes
Rhys James
Amana Khan
Izabela Kirschnerová
Charlotte Lee
Ella Winskell
Campus Comment
Alexander James
Ashna Mathur
Sam Norman
Opinion
Ross Bennett
Alex Dunn
Science
Elisabeth Göres
Isabel Lamb
Anthony Welsh
Sport
Senior editor: Katie Siddall (she/her/they/them) --k.e.siddall1@ncl.ac.uk
Tom Barlow
Arthur Ferridge
Elena Photiadou
Paige Rutter
Social Media
Head of Social Media: Autumn Keil (she/her) -- a.keil2@ncl.ac.uk
Life & Style
Senior editors: Gabbi de Boer (she/her) --g.de-boer2@ncl.ac.uk
Scarlett Welch (she/her) --s.welch11@ncl.ac.uk
Relationships & Blind Date
Ruby Butler
Georgia Purcell
Rebecca Wright
Lifestyle
Jenica Davis
Zahra Hanif
Molly Jackson
Fashion & Beauty
Samantha Seidu
Lizzie Yockney
Travel
Jude Parkinson
Ellen Pinch
Elžbieta Voverytė
Food & Drink
Daisy Harrison
Katy Anya McEwan
Abigail Roch
your abilities is something I will miss about this job. And that's it… the manifestos have been read and the policies have been debated, which only leaves us with one thing left to do… VOTE! Voting is open now and I urge you all to make sure you take the time to do so. Your voice is necessary to shape your Union!
I wish the best of luck to each and every candidate, and I’ll see you on the other side!
Much love,
Deputy Editor Sophie McNally (she/her) -- s.c.mcnally2@ncl.ac.uk
Culture
Senior editors: Carly Horne (she/her) --c.a.horne2@ncl.ac.uk
Rachael McCreanor (she/her) -- r.mccreanor2@ncl.ac.uk
Music
Lucy Bower
Rowan Christina Driver
TV
Castor Chan
Olivia Crowley
Imogen Smillie
Film
Rachel Carron
Mitchell Hall
Jessica McKeown
Arts
Louise Cusine
Martha Probert
Sarah Tunstall
Puzzles
Rhys Mason
Leo McManus-Andrea
72 years ago!
In light of this week's student debates for the NUSU elections, let's take a look at this advertisement for the 1951 student elections that was placed on the front page of our publication. Positions for: President (male only), VicePresident, Secretary, Assistant Secretary were posted .

1951

the Archives! Vol. 3, No. 7;
March
From
8th
-- Meg Howe xoxo
Warm Paws: Animal shelter raises £100,000 to combat rising energy bills
 Mitchell Hall - Film sub editor
Mitchell Hall - Film sub editor
Cost of living crisis forces appeal from a Newcastle dog and cat shelter
ANewcastle Dog and Cat Shelter launched the ‘Warm Paws appeal’ after an energy price hike threatened the operation of the shelter, which has been providing services for the last 126 years.
The appeal states their existing annual bill is set to quadruple from £50,000 to £200,000. This, amidst a cost of living crisis, not only harms the charity’s ability to operate but also sees families unable to afford to keep their pets, meaning there’s higher pressure on all shelters.
The appeal was initially launched in late 2022 and has since seen support from celebrities such as Alan Shearer, as well as seeing features on BBC Radio
Newcastle and BBC Look North. The community, have banded together throughout and through £100,000 worth of donations and have taken a large chunk out of the price increase, allowing the charity to continue to help re-home animals across their two locations, a road arrivals centre on Claremont Road and a re-homing centre in Benton.
Whether it’s individuals across Newcastle and the nation giving what they can, or local businesses donating money or services, the appeal has brought many people together for a worthy and adorable cause.
Alongside and around the appeal itself, the shelter has hosted a series of fundraising events and opportunities. This includes the fancy and charming ‘Paws and Prosecco’ ball at the end of last year, which looks set to return again
Families are unable to afford to keep their pets
when December rolls around, and their involvement in the Great North Run, for which they have charity places open
to potential runners. To keep up with these initiatives you can follow the Shelter’s LinkedIn
Newcastle Dog & Cat Shelter | LinkedIn , and to get involved yourself the appeal is still accepting donations, you can find
more information on that here Warm Paws Appeal – Newcastle Dog & Shelter (dogandcatshelter.com)

fashion frustration: Is Newcastle University’s environmentally sustainable ethos just for show?
Fast
Students furious at NUSU for promoting fast-fashion brand
Shein at Discover Newcastle Fair
Newcastle University’s Students' Union lands itself in hot water after hosting fast fashion brand Shein at Discover Newcastle Fair.
The immense student backlash received by Newcastle University’s Students' Union over its decision to host big name fast fashion brand Shein at its Discover Newcastle Fair in February has now prompted a rethink among SU directors over the promotion of fast fashion companies on campus.

Back in February, Shein were given a table at the SU’s Discover Newcastle Fair, where brand ambassadors offered students the chance to win a whole rack of clothes as well as vouchers in exchange for pictures with their branding and email sign ups.
Understandably, the reaction from students was so heated it was almost palpable, with people quickly coming forward to vocalise their disappointment, branding the SU’s decision as both “contradictory” and “embarrassing”.
Shein, a company with a fundamentally unsustainable model of clothes production centred around
fast fashion, is already well known for being one of worst polluters in the industry. The company’s excessive use of virgin polyester and large consumption of oil churns out catastrophic amounts of CO2 - 6.3 million tonnes a year to be exact - according to recent reports published on fashion sustainability. In a world aiming to cut global carbon emissions by 45% by 2030, yet where fast fashion companies are responsible for releasing more than 10% of these emissions, big brands like Shein are falling well below the target imposed to help combat global warming and are by no means positively contributing towards the shared goal that lies on the horizon.
Newcastle University, which prides itself on being ranked first in the UK for sustainable development, has been hugely vocal in recent years about its commitment and efforts to promote sustainable living, reflected in its webpage dedicated to environmental sustainability work and its very own sustainability team who focus on improving sustainability on campus. Yet, the partnership with Shein at the SU’s most recent fair is a complete contradiction and a far cry from the bold statement of being committed to “embedding social and environmental justice throughout our activity” and “taking action on the climate and ecological crises” promised on the
university’s website.
NUSU to amend approach to promoting fast fashion brands
When contacted, a Newcastle University SU spokesperson commented: “We are aware that some students have registered their frustration at Shein being part of yesterday’s Discover Newcastle ReFreshers Fair. We take the views of all students very seriously and, following
discussions between the Directors and Sabbatical Officers, we have decided to amend our approach to promoting fast fashion brands within the Students' Union building.”
From the SU’s statement, it appears that the fierce criticism over the last few weeks has had the desired effect and SU staff will now be thinking twice before making any more environmentally unfriendly decisions like inviting fast fashion brands to future events.
Yet, whilst the SU’s response suggests they’ll try to act with increased awareness moving forward and work with brands whose values are more in line with their own sustainability centred motto, the suggestion of “amending” their approach to fast fashion promotion only sparks more worries and questions than it really answers.
Now, many green-minded students are showing concern over what “amending” its approach actually means and whether their SU will cease to promote fast fashion brands altogether, or merely alter their way of doing so to align with the environmentally conscious image the university boasts.
Now the SU has landed itself in such hot water, only time will tell whether the university’s environmentally sustainable title it so proudly claims can actually be put into practice at future events - perhaps by promoting more sustainable brands or doing thorough research into a company’s reputation before choosing to partner with them - or whether it may actually be purely for show.
Image credit: Unsplash
THE COURIER Monday 6th
2023 News 3
March
Sub-editors: Poppy Bedford, Alice Holmes, Rhys James, Amana Khan, Izabela Kirschnerová, Charlotte Lee & Ella Winskell
Annie Rose Edwards
Image credit: Flickr
King's College London ‘Tory Society’ debate the reinstatement of the British Empire
 Madeline Davison
Madeline Davison
Controversy as the Conservative association of King's College London has issued a motion to reinstate the British Empire
The King's College London
Conservative association has faced severe backlash after hosting a debate motion which considers the reinstatement of the British Empire.
The society held the debate as part of their regular Port and Policy event. Days prior, the event was posted on their Instagram.
They declared the debate’s motions would be:
1. THW [this house would] scrap party members right to elect their leader
2. THW restore the British Empire.
People voiced their opposition,
claiming the debate was ‘vile’ and ‘shameful’.
People voiced their opposition, claiming the debate was ‘vile’ and ‘shameful’
Further criticism was launched at the society as the debate was operating “strictly off the record” which made many question the content of what was discussed.
The most prominent accusation was the glorification of genocide due to the actions of the British empire.
Union staff urged the event to be cancelled, but it was rejected on the grounds of free speech
In response to this post, Liberate KCL, a society which aims to decolonise and
end the attainment gap, stated that they would be holding an “emergency demo” which protests the event. The group said they had written to union staff urging the event to be cancelled as it was inherently racist, however, it was rejected on the grounds of free speech. While this led to the event being moved to University College London, there was still backlash from the UCL conservative society who stated they were “firmly in opposition to the second motion”.
Conservative Society members at UCL, LSE and UOW walked out
The UCL Conservative Society pressed for the motion to be dropped, however it was reinstated prompting a walkout from members of UCL, LSE and UOW.
NHS staff urge North Tyneside council to complete Whitley Bay seafront cycle lane
Construction
Last week North Tyneside Council received a letter from 54 current and retired medical professionals urging the construction of a planned cycle path between Whitley Bay and North Shields.
The joint cycle and pedestrian path was first proposed by the council in 2021, to be funded with £3.5m from Active Travel England and a further £750,000 from cycling charity Sutrans. The so-called “sunrise” seafront route would be 8km in length, leading from St Mary’s lighthouse at the very north of Whitley Bay to Tynemouth, before heading slightly inland and connecting to Northumberland Square and North Shields Fish Quay. The works have since been delayed due to funding issues.

Doctors and medical workers said building the route was vital for public health, as it would provide an opportunity to boost residents’ fitness in order to combat high local obesity rates. Its trafficcalming effects were cited as a way to promote cycling and walking
and enable more sustainable forms of transport. They also highlighted that the greatest benefits would be enjoyed by children and young people, as well as emphasising its importance for the environment, as it would help improve
air pollution and tackle global warming. It’s potential to boost local tourism was further mentioned.
The letter, which was signed by a range of health professionals including GPs, consultants, surgeons, nurses
and registrars, was also sent to North Tyneside’s elected mayor, Dame Norma Redfern. It stressed that “pushing ahead is a matter of urgency”.

It was originally proposed as part of the council’s declaration of a climate
emergency, in order to create a greener borough. It aimed to address conflicts between pedestrians and cyclists on the current shared-use path, as well conflicts between on-road cyclists and drivers. It would make physically active transport safer and more accessible, encouraging more people to adopt a healthier lifestyle, as well as increase the appeal to visitors of the beautiful North Tyneside coastline. Popular attractions like the Spanish City and Tynemouth Priory, as well as local businesses, would be made more accessible. It would also benefit the community by linking existing national cycle routes and providing connections to neighbouring boroughs.
The council has since stated it remains “fully committed” to the route’s construction and is expecting to share plans for its development very soon. The delay can be attributed to significant cost pressures, including increases in the cost of highway materials and construction. Inflation and a worsening wider economic situation, combined with council difficulties in securing sufficient funding can be cited as contributing factors.
5 Monday 6th March 2023 THE COURIER News 4
Sub-editors: Poppy Bedford, Alice Holmes, Rhys James, Amana Khan, Izabela Kirschnerová, Charlotte Lee & Ella Winskell
Emma Hunter
of cycle path between Whitley Bay and North Shields slowly continues as funding is limited
Image credit: Facebook @KCLConservativeAssociation
Image credit: Geograph_ R J McNaughton
Metro trains trialled in Czech Republic
New metro trains trialled in the Czech Republic before making their final journey to the UK
New metro trains from the Tyne and Wear metro line have been trialled in the Czech Republic to replace the old models. The new trains were built and tested in Switzerland, after which eight train drivers travelled from north-east England to test them in the Czech Republic.

The new trains are planned to go into service in the autumn of 2023
According to the BBC, the new trains are planned to go into service in the autumn of 2023 and will include features like linear seating, wi-fi, phone
charges, air conditioning and better access for wheelchairs.
Nexus, the operator of the Metro, spent £362m on a fleet of 46 new Stadler trains. The new models are set to replace the old that have been used since the network first opened more than 40 years ago.
According to the BBC, Craig Pearson, a Metro driver for 10 years, has been one of the first to try the new trains and said: “Everything is at your fingertips in the new drivers' cab."
"The layout is better and the computerised control systems are amazing. It's a huge jump from analogue to digital technology.
"The new train is very smooth, quiet, and comfortable to drive and will undoubtedly improve our working environment."
Head of the fleet at Nexus, Michael Richardson said there were 177 drivers who had to undergo training on the new trains.
"Everyone will get time in the special simulator ahead of driving one of the new trains on our network for real," he added.
Newcastle University professor wins the Laura Shannon Prize
A Newcastle lecturer has won the Laura Shannon prize for her book on diplomacy and peace in Europe

This year, the Laura Shannon prize was awarded to Stella Ghervas for her book entitled “Conquering Peace: from the Enlightenment to the European Union” published by Harvard University Press. Professor of Russian history at Newcastle University, her work on war, diplomacy and peace in Europe has been highly praised.
Each year it is awarded by the Nanovic Institute for European Studies at Notre Dame University in Indiana. This prize of $10,000 is presented to the European Studies book which “transcends a focus on any one country, state, or people to stimulate new ways of thinking about contemporary Europe as a whole.” It is one of the leading book prizes in this field.
The jury, constituted of a group of scholars from different universities, recognised it as a “highly original, analytically penetrating, magisterial narrative” in their statement. Praising it “for its present-day

relevance and practical applicability”, they added that “one can only hope that all professional diplomats, as well as politicians engaged in international affairs, will read and learn from this wise book”.
politicians should read this wise book”
The book covers the history of Europe for over three centuries, looking at political, diplomatic, military, legal and intellectual history. By comparing different processes of war and peacemaking achieved by diverse politicians, she explores how “since the 18th century, European thinkers and leaders have pursued lasting peace across the continent and fostered the idea of European unification”.
In response to this, Stella Ghervas declared herself as “thrilled and honoured to win this prestigious award and grateful to the distinguished jury members for this welcome recognition of the power of peace”.
To celebrate this major accomplishment, Stella Ghervas will be giving a lecture regarding new thinking in the study of Europe at the University of Notre Dame later this year.
Image credit: Unsplash
THE COURIER Monday 6th March 2023 News 5
Sub-editors: Poppy Bedford, Alice Holmes, Rhys James, Amana Khan, Izabela Kirschnerová, Charlotte Lee & Ella Winskell
Anna Nix
Margaux Martinez
“All professional diplomats and
Image credit: Wikimedia Commons


Northumberland County Council to double tax on second homes
Abigail Roch - Food & Drink sub-editor
If government legislation passes through parliament, new measures could be introduced to double tax on second homes
Owners of second homes and empty properties in the county of Northumberland could soon face a huge increase in their council tax if the government legislation is carried out.
Second homes are considered a significant issue in the county
The Levelling Up bill - currently awaiting royal assent – allows councils to enforce up to double the amount of council tax. Second homes are considered a significant issue in the county, particularly on the coast and in

the national park.
Deputy leader Cllr Richard Wearmouth – speaking at the council’s meeting on Monday – confirmed that the council will implement the measures as soon as April 2024, provided the government legislation successfully passes through parliament.

He said: “We will approve, subject to the levelling up bill, the implementation of a 100% empty-homes premium after April 1st 2024, and via the same bill implement a 100% premium for second homes in the county.”
Also speaking at the meeting, council leader Glen Sanderson said: “We’re deeply aware and very grateful to all those people who came up during the last two pandemic years who liked Northumberland so much that they spent their hard-earned money on buying second homes, which is great.
“But, the outcome in many places has been that it has meant less housing is available for local people. We feel that this might bring extra funding into it and ensure more local people can live locally.”
Go North East calls for more female bus drivers

Varsha Jayaprasad
Go North East intend to recruit more women and individuals from diverse backgrounds
Go North East, an organisation that operates local and regional bus services in County Durham, Cumbria, Northumberland, North Yorkshire, and Tyne and Wear, has taken an initiative to launch a recruitment campaign for female bus drivers in the past week. Currently, Go North East has a women workforce that amounts to nine percent of the total. This has been introduced at a key time, as occupations that have been seen as generally male-centric are seeing an increase in female employees.
Go North East's current female workera amount to 9% of the total workforce
Paula Ullathorne, a 42-yearold bus driver from Consett, had switched careers from being a health and social care worker to a bus
driver. She stated that "I'm not saying that it was an easy ride for me, but I did it. I didn't think I would [manage] and at times, I thought I wasn't going to get there - now I thoroughly enjoy it."
The 42-year-old also adds that "It used to be seen as a man's role, but this is the 21st century and we need to get more numbers up to be equal to the man."
Go North East has set a target to increase its woman workforce by 2025.
Ben Maxfield, Go North East's business director, told the BBC that they intended to recruit more women, and individuals from diverse backgrounds were given priority. He said that "we're looking for anyone with a licence, who can drive a car, who feels they would like to have a go driving a bus."
Graham Vidler, chief executive of the Confederation of Passenger Transport (CPT), told the BBC, "I think the legacy of them carries on and that's why we need to do everything we can, as Go North East is doing at the moment, to make sure that women know that they're welcome within our workforce, that there's a place for them, and we will and accommodate them fully and fairly."
The public transport scene is seeing a surge in female participation. With more such initiatives, there can be inclusive spaces in many other workspaces.
THE COURIER Monday 6th March 2023 News 7
Sub-editors: Poppy Bedford, Alice Holmes, Rhys James, Amana Khan, Izabela Kirschnerová, Charlotte Lee & Ella Winskell
Image credit: Instagram: @gonortheast
Image credit: Unsplash
"It used to be seen as a man's role, but this is the 21st century"
"Less housing is available for local people"
What can the MyCareer Service do for you?
a part time job to earn some cash on the side, or an internship to gain valuable insights into a particular industry, the vacancy directory is extremely useful.
When I first came to university, I was quite reluctant to make use of university services such as MyCareer, but I’ve now grown to realise that it has a lot to offer that I shouldn’t turn down.
At the start of this academic year, I realised I had an interest in marketing, but I have never experienced working in a marketing role. I used MyCareer to find an NCL Internship and applied for five different ones. In the end, I was successfully placed on a term-time internship, and I couldn’t be happier. Internships are a great way to try out a role and there’s no pressure for you to be perfect at it straight away. You get plenty of support throughout – and you get paid!

you can use to pinpoint what you’re looking for. I put ‘NCL Internship’ as a key word, but you can even choose a specific company, location or type of employment. It’s not limited to Newcastle!
Firstly, MyCareer is a brilliant tool to find work experience. Whether it’s


Even if you are not successful, it is still so worthwhile to apply and practise attending interviews. I have learnt so much from all the interviews I had to do, even if I wasn’t successful. It’s also a great way to build your confidence. When looking for a vacancy on MyCareer, there are a number of filters
Toast or Roast: Henry Daysh Building
Libby Griffiths
One of the busiest buildings on campus, is it a hit or a miss?
If I had to guess, I’d say Henry Daysh is the busiest building on campus. Endless seminar rooms, lecture theatres, and computer labs make the space perfect for all types of learning and teaching across all degree programmes.

As a journalism student, I was shocked to find out that Henry Daysh himself was head of the Department of Geography, which goes to show just how diverse and
versatile the building is.
While the building itself is already grandeur enough, over the Christmas period the gingerbread lattes and various other concoctions of syrups and sweeteners the cafe had to offer made the Henry Daysh an official toast in my eyes.
Although, I must say I would like to see more study space for such a crowded place, being crammed next to strangers and listening to the whir of milk frothers and dings of elevators isn’t the most motivating of study soundtracks.
I have also used MyCareer to book one-to-one appointments with the university careers service. The careers consultants are so supportive and can offer advice on a wide range of queries. Whether you need help with your CV or just a general chat about any worries you have, I really recommend booking an appointment, which can be in person or on Teams.
I went to one of my appointments completely unsure what to do and left feeling much more reassured, knowing what my next steps would be, and I was also provided with some further resources that came in very handy.
The battle of the the Toon's student nights
For someone who isn't much a fan of a stereotypical club night, I actually think ChachaBuchi is the perfect venue. Classy and chic, with a little something for everyone, it's definitely a contender for the best night out - student or otherwise Going earlier in the day means a spot for a range of food (including sushi and pizza), as well as some lovely chardonnay-based fondue. Saturday afternoons play host to live music and fans of a bottomless brunch can find it here.
For those club-inclined students, sister venue Howlers hosts all day parties on the weekend. Home to Newcastle's only ball pit par, live entertainment and Bonkers BingoChachabuchi/Howlers is probably the most chaotic venue for a

Whilst not an 'official' club night like the likes of Swingers at Grey's or Persistence at Tup Tup, I would argue that Tuesdays at Market Shaker are the best student night out.
Tuesdays are an underrated night to go out in my eyes - you can start in the Jesmond bars and make a whole night of buying £2 drinks.
So, why Market Shaker in particular? Firstly, Shaker's cheap trebs (pretty self-explanatory). Who is going to turn down getting drunk for less
Second, the music - songs that the majority of people will have at least heard if not know the words to sing
Thirdly, Shaker is an easy venue to navigate, in part due to its smaller capacity. I frequently wind up getting lost in Grey's, Tup Tup and Digital when heading to the toilets. It's more rare that you will lose your friends in Shaker even when it's rammed.
5 Monday 6th March 2023 THE COURIER Campus Comment 8 Sub-editors: Alexander James, Ashna Mathur & Sam Norman
Chachabuchi/ Howlers is probably the most chaotic
Carly Horne - Head of Culture
Roseanna Leconte
MyCareer is the University's online career development portal, but what does it offer and is it helpful?
Image Credit: Flickr
Jessica McKeown - Film sub-editor
I used MyCareer to find an NCL Intership and applied for five different ones
Image Credit: @NCLCareers
I left the meeting feeling much more reassured, knowing what my next steps would be
Public Domain
It's a great way to practise attending interviews and build your confidence
Image Credit:
Campus Comment 9
Motivation, morale, and the UCU strikes
 Grace Boyle
Grace Boyle
Does not having regular teaching impact student motivation?
Strikes have affected everyone and in many ways, disrupted student life with members of the UCU not teaching.
Lectures, seminars and timetabled classes add routine to our schedules and we plan our days around what we have, motivating us to make the most of our time on campus. Without a sense of routine and not having to wake up for 9ams, students find themselves not reaching for their laptops or wanting to leave their homes to do their uni work. The same goes for being given pre-recorded lectures and online resources. Many feel they can only teach you so much and staring at a screen for long periods of time does not feel gratifying, with distraction and the easy decision of taking a long break between the study periods.
Moral and motivation are intwined and generally we treat the strikes as a day off. We understand why the

teachers are striking and are cancelling lectures but at the same time, don’t we want to learn the content of the topics we are missing out on?
A big thing to consider when approaching the justification of missing out, the cost of little teaching time is that we aren’t just paying for lecture and seminar time. We are paying for the access to the University’s resources and opportunities it provides. Our degrees are what we make them to be and the effort we put in. It is our decision and our responsibility to make the most of it and choose to do our uni work. The strikes are a set back to our education but we should use it as a chance to motivate us to get
University strikes and our grades: Are we going to be struck dumb?
 Amelie Baker
Amelie Baker
How is students' missed learning time being taken into account for assessments?
How to defeat your dissertation
Jay Barber
Writing a diss is like what I imagine running a marathon would be like –long, tiring, and something that you regret signing up to at the midway mark. I know that it’ll all be worth it when I cross the finishline, but I’m not there yet. If I could go back in time, there’s a few things I’d tell myself to reduce the amount of tears shed and time wasted – hopefully my regrets can help someone who’ll be living in the library this time next year.
1. Take as many notes as possible when researching. You won’t remember what you were thinking when you highlighted a random sentence in 2 months’ time.
2. A blank page is intimidating –write something, even though it’ll probably be edited out.
3. Talk to your supervisor, friends, anyone who’ll listen. They’ll spot the things you become blind to over the hours spent rereading the same paragraph.

4. Along the road, you’ll feel as though you’ve lost the point you were trying to make. Try not to jump ship on your topic; reread, scribble some notes, it’ll come back to you eventually.
5. Go with the flow. Some days, no matter how hard you try, you’ll get nowhere. Be kind to yourself and try again tomorrow.
To those doing a diss, I'm suffering in solidarity
Fuelled by caffeine, the Robbo’s overpriced vending machines and the threat of the looming deadline, your dissertation will be written –and you can finally take the rite-ofpassage dissertation picture under the arches. To everyone writing their diss now, know that I’m suffering in solidarity.
And to anyone not writing their dissertation yet? Consider taking my advice, and buy your final-year friends a drink.
Why I'm nominating my lecturer for TEAs
Molly Jackson - Lifestyle sub-editor
University strikes: a complete and utter pain, especially when you turn up at 9am only to find the lecture hall but without a lecturer. Whilst this does mean more time in bed at home, how is our missed learning time being taken into account?
In all subjects there are systems in place aiming to mitigate the impact of missed content through ‘not assessing’ those missed subjects and topics. A comforting thought to know we won’t have to teach ourselves complicated theories that barely make sense even with a lecturer, but can the impact of so much missed learning time really be taken into account effectively? Whilst arguably this system might work for exams as certain missed topics can simply be excluded, this does little to combat the long-term impact on our education.
to miss the content in the first
For all subjects at higher education, learning has become not just about memorising facts, statistics and theories, but about their application and how they interact with other aspects of
our learning.
University education is about the development of our knowledge and thought processes, so when this development is interrupted, the long-term and short-term impact on each student across so many different subjects, is completely individual and diverse, and will go beyond just the effects on the grades of this semester.
It really does beg the question of how the strikes’ impact can truly be measured fairly and effectively, which of course it can’t be.
Following TEAs announcements, how important is a positive student/staff dynamic?
you can just tell that they have your best interest at heart. Even having a chat with tutors can help to ease your anxieties around assessments, you can bond in your mutual interest and in my experience, they are always understanding and willing to help anyway they can.
The only real solution is to not miss the content in the first place, which would require our lecturers to continue working under unfair, unequal conditions.
It's clear that the university system does not work: we pay for education, our educators do not get paid, and we do not get our education, despite the efforts of ‘non-assessment’ - a vicious cycle of a broken system where no one wins.
In my experience at university, the advice, support and feedback I have received from my tutors has been exceptionally important. Without it, I would have felt academically lost. A healthy and positive teacher-student relationship motivates and inspires students, and even though it is written in the job description to support, not all teachers excel at it, but in my case, those who go above and beyond for their students by listening and understanding deserve so much praise. It wasn’t until second year that I learnt the importance of office hours. You can spot a good lecturer through their relationship with them. An engaging tutor who is truly passionate about their module encourages students to sign up to meet with them, and even makes them mandatory during assessment periods to ensure no one is struggling. It can be daunting to any newbie making their decent down that narrow hall of offices for the first time, so a lecturer that is highly approachable and reassuring has always been my favourite kind because
As we near the end of the academic year, it becomes equally important to give back to those teachers who have supported and inspired you, which is
THE COURIER Sub-editors:
James, Ashna Mathur & Sam Norman Monday 6th March 2023
Alexander
Image credit: Unsplash
Image credit: Instagram @newcastlesu
The only solution is not
Image credit: VectorPortal.com
We pay for education, our educators don't get paid, and we don't get our education


His very best: a retrospective on Jimmy Carter
Jude Ventress
The 39th President of the United States and Nobel Peace Prize winner, James ‘Jimmy’ Carter is receiving end of life care. After an extensive career as a representative of his community of Plains, Georgia, and later his nation, we look back on Carter’s shortcomings and achievements.
It's fair to say Carter has had an incredible life and career, a peanut farmer from rural Georgia who would go on to be the leader of the free world. Carter started off by serving in the US Navy for 7 years, and upon leaving the Navy he took up the family business turning around the struggling peanut farm.
He was a peanut farmer from rural Georgia who would go on to be leader of the free world
In 1962 Carter made his debut in Georgia politics, being elected state senator for Georgia’s 14th district. During his two terms there he focused on education, an area he would take all the way to the White House creating the
Department of Education in 1979.
Carter took his political career to the next level when he became governor of Georgia in 1970 after an unsuccessful attempt in 1966. During his campaign Carter sacrificed his personal integrationist beliefs and took endorsements from segregationists for political gain - a crucial error that would forever go on to stain his legacy.
During his term as governor, he was seen as a progressive, increasing the
number of African Americans working in Georgia’s government by 25% and streamlining the state’s bureaucracy.
In light of George McGovern’s failed democratic presidential bid in 1972, and Nixon’s Watergate Scandal, Carter decided to run for president.
Despite being a relative unknown and facing a field of 17 opponents in the 1976 Democratic primary, Carter won. He then went on to fight and win the general election against sitting President
Ford. Carter won with a majority of 297 electoral college votes proving to his detractors, as his campaign slogan said, Carter was ‘Not just peanuts’.

Once in the White House, Carter faced a looming inflation crisis and a growing unemployment rate that, by June of 1977, had reached 7.1%. Attempts to curtail this, by raising interest rates, had an adverse effect by triggering a recession.
Even though the administration was facing a tumultuous economic situation, it was able to make some achievements such as expanding the national parks’ lands, tackling the energy shortage, and improving the social security system.
The defining event abroad of Carter’s presidency was the Iranian Hostage crisis, where 52 US diplomats were held for 14 months only to be released on the day Carter left the White House.
The near-constant media scrutiny significantly hampered Carter’s last months in office.
Carter did make some significant progress on the international stage with the establishment of diplomacy with China, and the successful negotiation of the SALT II nuclear treaty with the Soviet Union.
Although Carter had some accomplishments both domestically and internationally, they were overshadowed by his failure to control the desperate economic situation and resolve the lengthy foreign policy crisis in Iran. Ultimately this resulted in his
Starmerism: Ideologically vague, unamibitious and disappointing
Harry Sanderson
One writer discusses his dissatisfaction with Keir Starmer's leadership of the Labour Party
Right from the beginning of Starmer’s leadership, there has been very little clarity about what his true political beliefs are, or what he intends to do when in government.
As the third anniversary of his leadership approaches, the foggy picture has become gradually clearer, unfortunately leaving little to be inspired by.
Starmer’s initial pitch to the

commitments he made have been broken while in opposition. After much obfuscation on the subject and many awkward TV interviews, he eventually made his intentions clear, proudly proclaiming that he was “ready to break pledges to make Labour electable”.

quickly. It’s easy to imagine powerful Tory attack lines at the upcoming general election: Starmer has lied to get elected before, what makes you think he won’t do so again?
The popularity of the policies that Starmer has decided to drop make his tactics seem particularly bizarre, with the 2017 and 2019 Labour manifestos having broad popular support despite the individual unpopularity of Corbyn.
The reasons for this decision are twofold, both ideological and financial.
defeat in the 1980 election to Ronald Reagan.
Given that Starmer has made honesty and integrity his main selling points to the public, he needs to be impeccably consistent in his honesty if he hopes to translate it into an asset for electoral success. Although Labour are currently 20 points clear in most

Starmer’s ideology is heavily informed by figures on the factional Right of the party, such as Peter Mandelson, who are semi-religiously devoted to the idea that Labour can only be electable if it is Centrist. While there may have been some truth to this in 1997, thirteen years of austerity and a cost of living crisis have created a pressing demand for radical reform. While Starmer derides

provide lasting improvements to people’s lives, he is guilty of exactly this himself by shying away from any significant commitments to spending or taxing the rich.
It is also impossible to ignore the recent shift in how the Labour party is financed. As membership numbers plummeted during Starmer’s leadership, Labour cannot continue to be a financially self-sufficient mass membership party. This has led to Starmer seeking corporate funding from big businesses and wealthy individuals, signalling a quid pro quo agreement that he will act in their interests.
As Starmer is likely to win power, it is worth considering why most of the beneficial changes made by Blair’s government were eroded so quickly by the Tories. It wasn’t that Blair
Since leaving office, Carter has been an advocate for human rights and a supporter of multiple charitable causes. Most notably his work with the charity, Habitat For Humanity, who he's worked alongside with for more than 35 years - building homes for the homeless and disadvantaged.
Jimmy Carter was one of those presidents who was often termed a 'lame duck' - but lame he was not. Establishing the Department of Education and the Department of Energy, playing a key role in the Arab-Israeli conflict and a noble post-presidential life. Upon the writing of this article, Jimmy Carter is still alive. That will not last forever, it will likely not last until publication of this article. But it was a life well lived, and a duty well served in the eyes of the American public. God rest his soul.
#StandWithIran
Isabella Castello-Cortes
Venture past Haymarket at the weekend and you will find Stand with Iran, a North-East group fighting for Iranian freedom. Despite protests continuing and the Iranian Regime’s response becoming increasingly aggressive, Iran is slipping out of our headlines. Where our mainstream media are failing, groups like Stand with Iran have had to step in, reporting breaking news, keeping what is really going on in Iran front and centre.
The theocratic regime in Tehran responded to the demonstrators not with dialogue, but with extreme violence. Demonstrators continue to be arrested, tortured and murdered. The most basic human rights have been trampled on with more than usual brutality – the regime knows it lacks legitimacy, its only concern is to stay in power. If there were ever an occasion for the UK government to take a stand, this was it. Parliament’s response has been one of gesture politics and platitudes. Particularly shamefully, the Tory administration has failed to protect Iranian journalists working here, even suggesting they move Iran International TV (a key opposition mouthpiece) to the US instead. Were our Foreign Secretary, James Cleverly, serious about supporting the Iranian opposition, he would have shut Tehran’s Embassy in London and thrown Iranian ambassadors out of the UK. He should have already declared the IRGC the terrorist organisation it so clearly is. Stand with Iran is one of the many groups that continue to hold our government accountable. If you want to learn more about Stand with Iran and help fight the suppression of women across the globe, join Amnesty International's Intersectional Feminism event on 21 March.
THE COURIER Sub-editors: Ross Bennett & Alex Dunn Monday 6th March 2023 Opinion 11
Starmer's ideology is heavily influenced by figures on Labour's factional Right
Image credit: Jimmy Carter [PastDaily.com], Mujahideen [Flickr], Peanuts [Istock.com], Ronald Reagan [CrooksandLiars.com], Blue [TheHomeDepot.com], Gerald Ford [CriticsRant.com], Flag [Blogspot.com]
Ultimately this resulted in his defeat in the 1980 election to Ronald Reagan
Image credit: Wikimedia Commons Image credit: Flickr Image credit: Wikimedia Commons

The Last Of Us: How real is the threat of fungi to humanity?
Jessica McKeown - Film sub-editor
Looking at the science behind the likelihood of a real life attack to humanity seen in the hit show The Last Of Us
HBO's adaptation of hit Playstation exclusive game The Last of Us has been gracing our screens for the past month. Technically classed as a zombie apocalypse, the infection that cripples humanity is actually fungal in origin. Writer Neil Druckmann took inspiration from the fungal Cordyceps infection that, for now at least, is infecting insects. However, The Last of Us prompts the question: what if it evolves to infecting humans?
Viruses and infections have long been the tool of science-fiction and dystopian stories but the COVID-19 pandemic
has made the threat of outbreaks sweeping the world all too real. Fungal infections are not so fictional - take yeast infections for example. Belonging to the Candida genus, yeast infections are incredibly common and are treated with antibiotics. To those with compromised immune systems, fungal infections can pose more of a threat with research indicating an estimated 1.7 million deaths per year.

The Ophiocordyceps unilateralis featured in The Last of Us is a mutated strain of the fungus found in ants. Spreading through spores, the cordyceps attaches to the exoskeleton and begins to alter the behaviour of the host with the goal of survival and dispersal. Mind altering fungus are more common than you might think - what do magic mushrooms do again?
As tthe opening scene of the show highlights, cordyceps cannot survive humans' body temperature, but uses global warming to imply it may adapt to survive higher
temperatures in the future. In reality, the World Health Organisation released a report last year that identified the 19 "most wanted" fungal pathogens that are most dangerous to humans. There are an estimated 12 million species of fungi worldwide and the majority have never been categorised. In terms of the Ophiocordyceps species in particular, over 200 species have been identified that can infect hosts from 10 insect orders along with spiders. Included in WHO's list is Coccidioides which are soil dwelling fungi that can be found in Mexico, South America and south west US. The fungi can cause Valley Fever which is similar to the flu and infects roughly 150,000 people in the US each year, with around 75 dying from it. It has been observed that the range within which the fungi is found has increased, being found as north as the state of Washington. According to to reports by the CDC, cases of Valley Fever have gone up 400% between 1998 and 2015 suggesting climate change is
My, what delicious wee you have: The curious sex life of giraffes
Alice Saunders
Male giraffes have a highly unusual way of determining, or should that be tasting, when female giraffes are ready to mate
The last time you were scrolling through Hinge and matched with someone, did you find yourself wondering what their urine would taste like? The answer is probably no (at least I hope). Unfortunately, that’s not going to cut it for a male giraffe. Researchers have found that a male giraffe will dip their tongue into a female’s urine stream as a way of determining if she if ready to mate.


Giraffes are not alone in this urinetasting behaviour, however most animals will investigate urine on the ground. We can give giraffes a break though as due to the length of their necks it would be quite a lot of effort and even potentially dangerous to reach all the way to the ground.
Giraffes are not alone in this urine-tasting behaviour
When a male likes the look of a female he will send her a not so subtle signal that he is interested. This could be a shoulder bump or a small kick to the side. This signal is very clear: I want you to pee. Of course the female doesn’t

Mucormycosis, also known as "black fungus syndrome", is a dangerous but rare fungal infection that doctors believe has appeared to have capitalised on the weakened immune systems as a result of COVID. The symptoms match the ominous name - blackened skin, blurred vision, facial swelling, and potentially comas. Fungal infections do not transmit between people but is usually picked up from the environment. Take murcormycosis as an example. Chances are you will never pick it up in the UK but if you were in India, it is 70-80 times more prevalent. So, are fungal infections a bigger threat to our health and the future of humanity than we realise? Chances are if you have a healthy immune system, you will be fine in the face of a fungal infection. Efforts will likely focus on protecting immunocompromised individuals. With so many fungal species and antibiotic resistance on the rise, scientists have a difficult task on there hands. Fungal infections may be a potential threat in the future, but fear not, a Last of Us style outbreak seems unlikely.
Gagging clauses between oil giants and museum
Francesca Read-Cutting
The Science Museum in London has had its credibility questioned for having a gag clause in its contract
The Science Museum in London and the Norwegian oil and gas company Equinor have recently come under scrutiny for a gag clause in their sponsorship contract.
Similar cases have occurred in the past with other oil companies (e.g. the Natural History Museum and a Danish oil company). The clause prevents the museum from making any statement that could damage the sponsor's reputation.
Many are concerned about the impact this has on the museum's credibility and whether science can truly be unbiased when it is legally bound to remain silent. Critics question whether it is the duty of scientists to report the truth rather than take money from international oil companies.
The Science Museum's latest exhibition 'Wonderlab' aims to 'inspire curiosity and fuel imagination' through interactive experiences. However, certain topics are off-limits due to the gag clause, leading to filtered information.
While the museum and Equinor claim that the clause is standard practice in sponsorship
contracts, it raises concerns among environmental groups about the museum's ability to discuss the true impact of the oil and gas sector on the environment. The amount of money exchanged for the sponsorship has not been disclosed.
Equinor had record annual earnings of £62bn that juxtapose uncomfortably the burden of the energy crisis and soaring cost of living experienced by ordinary people.
Critics argue that the museum has lost credibility by not being able to discuss the true impact of the oil and gas sector while museums claim that large corporate sponsors do not significantly influence the exhibitions.
However, insiders have revealed attempts by oil companies to control presentations of climate change programmes. The Science Museum has stated that it will no longer include gagging clauses in new agreements. The sponsorship agreement with Equinor ended in March 2022, but many still believe that the damage done to the museum's credibility will take a long time to repair.
Scientists are traditionally discouraged from engaging in political activity and discourse in case it impinges on the credibility of their research.
However, there is a difference between allowing your worldview to impact your research and your research informing your worldview. Scientific findings must meet the basic criteria of being repeatable. Manipulated results, and omitted evidence, are unlikely to be replicated and therefore exposed.
THE COURIER Monday 6th March 2023 Science 13
Sub-editors: Elisabeth Göres, Isabel Lamb & Anthony Welsh
Image credit: Unsplash
Image credit: Pixabay



















Whether you're looking for love, a laugh or just something to do; The Courier's Blind Date is still open for applications! Calling all single NCL students! SCAN TO SIGN UP: Image credit: Unslpash Image credit: Unslpash Image credit: Pixabay Image credit: Pixabay
The burden of emotional labour: equal or not?
 Sohpie McMillan
Sohpie McMillan
Remembering birthdays, shopping lists, allergies, favourite foods, what is running out and needs to be replaced, realising when someone is not healthy and needs looking after, smiley customer service. All of this is emotional labour that mostly falls on women, particularly in relationships and the family dynamic. Emotional labour falls disproportionately on female workers, leading to an expectation that all women will manipulate their feelings and the appearance of their feelings to satisfy the expectations of their job position and the facing of customers. This pressure often doesn’t stop on the return home to family or partners - where they are still expected to keep up a supportive attitude and emotionally process for herself, her partner and/ or friends.
The expectation falls on women to be the organisers and micromanagers - while others may be willing to perform household tasks, the realisation that these tasks need doing, and the delegating of them commonly falls on women,

defeating the point of someone else performing the tasks in the first place. The willingness to do cleaning tasks for example is great, but the issue lies in the initiative and perceptivity. Performing emotional labour such as this, as well as acting as a therapist for those around them, is something women are often taught to accept as their duty and responsibility from an early age. The idea that women are always biologically programmed to be better emotion processors than men, according to gender sociologist Lisa Huebner, still has no biological basis; simply we find excuses as a society to push women and girls to be responsible and to allow men a pass. Even conversations and arguments about imbalances of emotional labour become
A love letter to female friendships
 Marina Snyder
Marina Snyder
How can we appreciate the gift of female.
Afew months ago, a trend surfaced on TikTok that focused on highlighting how valuable female friendships are and how much these friendships meant to women. And honestly? I’m 100% here for it. The female friendships I have and have had in my life have been some of the most vulnerable, impactful and special relationships, and is something I think everyone deserves to have at one point in their lives.
I think the reason these types of friendships work so well is that regardless of what kind of person you are, there are some shared experiences of womanhood. Whether it is the excitement of receiving a text from the person you really like or the pure fear of walking alone at night; these moments and feelings can be shared and creates a kind of solidarity that makes you feel less alone. Whether scared, happy, excited or sad, women have an amazing capability to empathize on a whole other level, and personally, it makes me feel comforted in a world that is often, very isolating.
I know some people who will affront these types of female-based friendships, “it’s too much drama”, they will say. But how could you pass on the idea of friendships that are wholeheartedly vulnerable? Being able to share your hopes, dreams, fears and secrets, and still being loved and cared for. I think any amount of so-called ‘drama’ is worth that.
The viral sound “Oh how I love being a woman” that rotated around social media is only truly encapsulated through these female friendships; pictures and videos of drinking wine and screaming to breakup songs, helping
each other get ready for a night out, laughing and crying as you experience the ups and downs of life together. It’s these minuscule moments that really make you appreciate these friendships. It’s when you all go to the bathroom together on a night out, it’s when your friends hold back your hair as you throw up over the toilet, feeling shit and ugly but they don’t leave your side, it’s staying up till 2 am talking about how misunderstood you feel by the men in your life, it’s laughing until your stomachs hurt, binge-watching Gilmore Girls, ranting about your bad day at work, offering advice and words of wisdom...It’s all these experiences and more that make you truly appreciate the women and, their friendship, in your life. So here is a shoutout to all the female friendships, both mine and yours. Feminine friendships: you are truly something special appreciative of.
emotional labour - conversations which are again, often started by frustrated women.
Part of this is due to the patriarchal gender roles and toxic masculinity that undeniably affects all sides - men who are expected to remain isolated and stoic in front of other men find themselves confiding and breaking down in front of women, investing their emotions into her, rather than working through them properly, as she is the only one allowed and expected to display the emotional intimacy.
Shame is another aspect, shame that men experience after showing signs of weakness, and shame women experience for failing to meet unrealistic and complicated expectations - these issues work in a cycle to continue the status
quo. It appears that one of the few ways out of this cycle is to continue encouraging communication, as well as encouraging and allowing men to confide in other men, and professionals who are equipped to deal with the issues they may have - till this becomes more widely recognised and received, the pressure will likely remain on women, and a quick glance on the comments of online discussions about this shows that we still, sadly have a long long way to go.
The nature of nudes
Anna-Louise Davies
How comfortable can you get with
nude images?
The taking and sending of naked images of oneself is still seen as relatively taboo, but should they be recognised as a tool for empowerment? Nudes are often presented to us in the media in the form of warnings, with cases such as the leaking of celebrity naked images or stories of revenge porn. However it is not often considered in a positive light. Many people maintain the belief that taking such photographs of oneself inspires greater body confidence and self love.
It must be stated however, that whatever the intent may have been by the person capturing the image, it must be consensually taken and sent by an adult to an adult without coercion. There are those with what are now increasingly considered ‘old fashioned views’, who hold serious concerns over the sharing of such images and are of the opinion that they make the person in the photograph vulnerable. This is not an entirely misplaced concern due to the matter of ‘revenge porn’, whereby following the end of a relationship, out of spite and anger, one of the partners shares the intimate images that were previously sent to them by their former partner, without their consent. This offence carries a sentence of up to two years in the UK.
Naked images may be taken or sent in many contexts. Some people may choose to take a nude photo of themselves in a moment or heightened body confidence and therefore want to capture the moment. Others may use such images as a way of exploring a new sexual avenue with a partner, potentially even using it as a type of foreplay in the lead up to a long awaited reunion. It is becoming increasingly popular to view the taking and sending of these images as extremely empowering as it makes them feel sexy, desirable and more accepting of their body.
Nudes are also occasionally considered to be degrading to the person in the image as they are being sexualised and objectified, however, sexual arousal is not always the sole purpose of such such images, with body confidence being a significant factor. It should also be noted that it is women who are primarily associated with nudes and often in a negative and objectifying light. This is a misogynistic bias which is exacerbated due to news stories in recent years of celebrities, such as Emily Ratajkowsk, having their intimate photographs leaked online, marking a violation in their privacy.

THE COURIER Monday 6th March 2023 Relationships 15 Sub-editors: Ruby Butler, Georgia Purcell & Rebecca Wright
Men who are expected to remain isolated and stoic in front of other men find themselves breaking down in front of women
Image credit: [pixabay]
Laughing and crying as you experience the ups and downs of life together
Image credit: Pixabay
It is becoming increasingly popular to view the taking and sending of these images as empowering
Image credit: [pixabay]
How women are unfairly expected to put in more mental work
It must be consensually taken and sent by an adult to an adult without coercion
Queerness and neurodiversity: how are the two identities linked together?
Jay Barber
One of our writers explains the overlap between the LGBTQ+ and neurodivergent communities.


Idon’t mind that you’re like that, as long as you don’t make it your whole personality.”
“It’s a trend, haven’t you seen that everyone is labelling themselves that these days?”
If I could play bingo with bigotry, these phrases could be crossed out twice – a combination of a queer identity and a late diagnosis of ADHD makes me the golden child of those claiming Gen Z collect labels like it’s a competition. Amongst the media panic surrounding selfdiagnosis and “everyone suddenly being bisexual”, there’s actual, scientific evidence that links LGBTQ+ identity and neurodiversity. According to a recent study from the University of Cambridge, autistic individuals are approximately 8 times more likely to identify as non-heterosexual than non-autistic peers, and there is similar research indicating that autistic people are more likely to identify as gender diverse. Although research in the field is sparse, the same ties are being made to those with ADHD.
Coined as the “neuroqueer” intersection, the overlap between these marginalised identities is a

This is a discussion that has the potential to make a lot of positive change
growing topic of discussion – a discussion that has the potential to make a lot of positive change, or, if taken up by the wrong people, continue the spread of misinformation. Speaking solely from personal experience, the tie between these two communities makes sense. My ADHD diagnosis just had its first birthday and it’s been a long, ongoing process of learning how my brain works differently to others’. In some ways, the diagnosis gave me more questions than answers, especially as my psychiatrist heavily suggested I consider being screened for an autism diagnosis. Did you know that between 20 – 50% of those with ADHD are also autistic?
We can regain control of the narrative ... and work towards a more inclusive, accessible future
While I personally haven’t pursued another diagnosis (for reasons that would require a whole
Rant of the week: The ick in "pick me"
Rosie Brennan
We've all acted like a "pick me " girl at least once in our lives, but what makes them so annoying?
The TikTok-ification of modern language has brought about some of the most ridiculous terms I’ve ever heard in my life. But one thing I think I’m glad it’s exposed is the phenomenon of the “pick-me” girl.
The general internet definition of the term explains it as a woman who seeks male validation directly or indirectly by insinuating that she is unlike other women. In my experience, the implicit ambiguity of this definition seems to have created some debate around what actually constitutes as a “pick me” girl.
Some people see a woman claiming to like football and immediately brand her as a “pick me”. Or a woman explaining that she doesn’t enjoy wearing make-up instantly being dubbed as the worst feminist of all time. But a woman simply enjoying “non-feminine” things (whatever on earth that means) does not make her some sort of raging misogynist.
This misuse of the term just feeds misogyny further. The entire point of talking about “pickmes” was to bring to light how some women feel the need to tear other women down in order to appeal to men. Because God forbid the world was designed for women to actually just get along with each other, rather than pit us against one another.
Despite this, most of us, at some point or another, will have encountered a pick-me girl. They’re fairly easy to spot. Most of their personality comes down to “not being like other girls” because their view on “other girls” is one fuelled by Andrew Tate-like perspectives.
“Other girls” wear too much makeup. “Other girls” cause too much drama. “Other girls” don’t like sports.
A pick-me girl could simply “NEVER wear that much makeup”, they’d rather die than look “fake”. They’re probably not friends with other girls, purely because girls cause so many arguments, no other reason. You know what girls are like, catty and petty and get overemotional over the most miniscule things, who on earth would want to be friends with them? Men aren’t like that, are they? They’re level headed, honest and definitely haven’t started every war in history ever.
Men aren't like that, are they? They're level headed, honest, and definitely haven't started every war in history ever
Looking back on it, I’ve definitely done some very “pick-me”-esque things in my life. Most of it came down to jealousy and internalised misogyny. I wanted to be like other girls I knew, which I knew was physically impossible, so making them look cringey or stupid for simply enjoying things was a better strategy in my mind.
I distinctly remember primary school, thinking I looked incredibly cool to boys when I told them I wasn’t like other girls because I just HATED One Direction and Justin Beiber, even though I’d dance around to both in my room at age 7, like the rest of the world. After quickly realising that I did not in fact look cool, I came to the conclusion that I actually wanted to be like other girls. I mean, they got to see One Direction live and I didn’t because I was too busy pretending to be above it all, so who had more fun there?
other article to explain), I’ve had a lot of time to consider how these things tie to my identity as a queer person, specifically as a lesbian who doesn’t connect with traditional "womanhood".
a higher chance we’ll question [the rules], disobey them, and create an identity of our own
Neurodiverse people, including myself, often look at social norms in a different light: the unspoken rules that dictate the performance of gender, the do’s and do-not’s of sexuality, the guidelines everyone else seemed to understand at 13 while we, apparently, weren’t given the memo. When the rules presented to us just don’t make sense, there’s a higher chance we’ll question them, disobey them, and create an identity of our own.
Being defined as an “other” can be both isolating and liberating, but finding a community of those like yourself makes the whole experience a lot less lonely. By amplifying the voices of queer and neurodiverse communities, we can regain control of the narrative surrounding our identities and work towards a more inclusive, accessible future.
The deceptive dangers of online catfishing
Mia Dale
One of writers discusses the consequences of catfishing and why social media isn't always safe

We're all guilty of spending hours endlessly scrolling through social media, comparing our lives to others, and even speaking to strangers online through dating apps … but social media can be an extremely dangerous space. Catfishing, whether that being edited photos or posing as a completely different person, is an extremely common form of online deception that is carried out for a multitude of reasons - ranging from a mild ego boost to more extreme, dangerous intentions. So, when you find yourself encapsulated in the world of TikTok and Tinder, be careful not to trust the wrong people… Insecurity is a common motive behind catfishing online, as people drastically edit photos to create the ‘perfect aesthetic’. We all follow influencers who seem like they have the perfect lives … great wealth, success, and beauty. Whilst their manipulation of photos may derive from insecurity itself, it only breeds further insecurity and low self-esteem in their followers, as the pressure to adhere to beauty standards is already so prevalent today. From the Kardashians smoothing out their cellulite to Tana Mongeau sharpening her bone structure, catfishing sets unrealistic expectations of beauty and lifestyle, subsequently creating an unhealthy culture of comparison. Alternatively, financial gain, revenge, and harassment are just some dangerous examples of why people may catfish online, which are commonly achieved through dating apps, with the creation of fake profiles leading to victims trusting strangers. I’m sure we all have a friend who has catfished themselves as a joke on Tinder to try and find a good match, but those who do this with
more dangerous intentions can cause significant harm. Sadly, many people fall for their deception, believing they are in secure online relationships. Once this trust has been built, the catfish is able to manipulate their victim, fraudulently taking their money or convincing them to meet in person with darker intentions. Just like the Netflix show Tinder Swindler, where multiple women were conned out of millions of dollars after trusting someone they matched with, people are easily tricked into sharing details - which unfortunately happens too frequently. This is becoming increasingly common and proves that we must be more vigilant when
There are many reasons why catfishing happens, and also many ways that online deception can occur. Look out for strangers having few friends on social media, no photos, or asking for money and personal details. Whatever the reason or method, catfishing can be extremely harmful to its victims:

5 Monday 6th March 2023 THE COURIER Lifestyle 16 Sub-editors: Jenica Davis, Zahra Hanif & Molly Jackson
Image credit: Unsplash
There’s
Image credit: Unsplash
Sharing our story: celebrating LGBTQ+ History Month at the Students' Union
Jenica Davis & Zahra Hanif - Lifestyle Sub-editors
Here's what went down at the LGBTQ+ Society's annual event
On the 25th and 26th of February, Newcastle University’s LGBTQ+ Society hosted their annual weekend-long event in honour of LGBTQ+ History month – full of celebratory crafting activities, interactive workshops, and talks surrounding queer marginalised identities. Lifestyle sub-editors, Jenica Davis and Zahra Hanif, headed down to the Students’ Union to join in on celebrating LGBTQ+ history.
To start off Sunday's session, Phil Douglas, executive producer of Curious Arts, came in to discuss with us all about queer culture. Curious Arts is a non-profit organisation based in Newcastle that champions local artists and audiences who are a part of the LGBTQ+ community. Their projects and events celebrate and represent the wider LGBTQ+ community and the queer identities that often go unseen. Douglas explained how the charity was founded with the idea of inspiring curiosity surrounding queer culture – hence the origins of the organisation’s name. They recognised the harmful stigmas and one-dimensional views attached to the queer
community and to pride events in particular.
Curious Arts aims to be a part of the action and are determined on contributing to the change that they want to see within the community. Recalling the popular saying, Douglas reiterated to us that “you can’t be what you can’t see.” Through their projects, Curious Arts brings visibility to all sectors of queer culture, committed to creating opportunities that embrace art in the North East. They have plenty of upcoming events, such as an evening of live music and entertainment at The Magic Hat Café on the 30th of March! It is certainly worth checking out Curious Arts on Instagram: @curious_arts.
Next up was an artsy workshop
Financial feuds: why lending money is risky
Samantha Seldu - Fashion and Beauty Sub-editor
Do you ever feel the heat after lending money to a friend or family member?

The topic of money and finances can be a very touchy subject for everyone and can often be quite difficult to navigate. This conversation can become especially difficult when it comes to close people in your circle. Despite this, we all need money to live and these conversations have to be had.
Asking for, lending, and borrowing money has been a trade that has existed for as long as money itself has existed. It is natural that we won’t always have money readily available for us at certain points in time, and thus, borrowing sums and paying it back is a common practice. Needless to say, when it comes to friends and family, we tend to feel much more sympathetic to their situations to the extent where some people may not expect them to pay back any borrowed funds. Whilst, in principle, this seems quite wholesome, money can cause very messy situations within familial and platonic relationships.
led by queer content creator, Ella Willis. Whilst we were all therapeutically drawing and scrapbooking, Willis discussed with us the connection between neurodiversity and queer identity. Willis is also the founder of the Canny Queer Collective (Instagram: @cannyqueercollective) which is a Newcastlebased collective that hosts casual events and meet-ups for queer folks. From picnics to poetry nights, it is an inclusive, safe space for members of the LGBTQ+ community to make connections with one another. If you are in search of a friendly queer community in Newcastle, look no further!
Following lunch was an interactive workshop/discussion led by Ste Dunn of Northern Pride. We were each given sheets to brainstorm our ideal vision of what pride should be, and what was stopping us from reaching this, as well as what could help us get there. These were taken on to provide feedback to inform their event plannersit meant a lot to see our voices genuinely heard and valued in this way. Northern Pride is a charity that provides an array of LGBTQ+ events, including an annual Pride Festival, as a means of celebrating our community as well as providing information to us and our straight
allies. Instagram: @northernprideuk.
Simply put, lending money to friends and family shouldn’t have to be so complex. It is the typical trade of ‘I’ll give you this and you can give it back


later’; should everyone follow that formula, there would be no problems. Issues arise, however, when family and friends don’t follow this formula or follow it on their own terms. In the same way you would feel more inclined to help someone you care about, someone you care about may feel more inclined to overstep privileges and boundaries because they know you. Things like this tend to lead to a sense of entitlement to your finances and asking for what you’re owed becomes difficult, especially when gaslighting gets involved (comments like “we’ve known each other for years why would you do this?” or “we’re blood related you can’t treat family like that!”). It is because of this, we see the end of many friendships or the breakdown of family bonds. The most important thing is to create firm boundaries and make sure they are not overstepped. Just because someone is a close friend or a family member doesn’t mean that they have full access to what you have rightfully earned. Lending money to friends and family is never wrong , and wanting to help them out when they are struggling financially shows that you do care about them. Even with this, always stand firm on how much and how often you lend money, and be more firm on them giving it back. How you assert yourself can also inform how people (including friends and family) treat you, so create your boundaries and enforce them, only being flexible when you have to. This way, you can avoid potential financial feuds that could shake your relationships with
Lastly, we wound down by painting queer tote bags. It was the perfect end to the weekend, as we chatted amongst ourselves while representing ourselves through brush strokes. I spoke with LGBTQ+ Society President and key organiser Jay Barber about how they thought the weekend had gone. They told me: “Continuing the LGBTQ+ History Month conference has been one of my main achievements as this year’s president of the LGBTQ+ Society. The conference has taken place each year since 2019, even moving to Zoom during the COVID lockdowns, and it feels amazing to have continued the legacy of past committees. This weekend focused on creating a sense of community and bringing together LGBTQ+ students and allies to learn about our history, discuss hopes for our future and hear from some amazing local guest speakers. I’m so proud of our little committee and hope that everyone who joined us had a good time!”. To get involved with the LGBTQ+ society, check out their Instagram: @ ncllgbt.
Sustainable self-care: small steps to take

favourite song. Music is good for the soul.
Everyone has their own way of defining self-care. I like to think of self-care as simply being kind to yourself. We all have good days and bad days. Sometimes you don’t want to get out of bed. That’s okay. On those days, just taking a shower is enough and that is a form of self-care. There are small things you can do that don’t have to be expensive or time consuming. You don’t have to take up yoga or start mediation. If that’s what floats your boat then great, but of course everyone is different. Here are some little things you can do to help look after yourself.
Exercise and enjoying the outdoors – if you’re short on time or not a fan of going to the gym, why not take a walk? Newcastle has
Calm your mind – life is stressful, especially for university students. This can lead to feeling overwhelmed or burnt out. This is completely normal. It’s important to recognise when you’re starting to feel this way and what you can do to relax. Step away from your laptop. Put your phone down. Give yourself twenty minutes and get a snack, watch an episode of your favourite TV show, or listen to a podcast. Find something small and simple to give your mind a break.

Slow down and be okay with saying no – this is something a lot of us (me included) struggle with. We make so many plans that we wind up trying to cram too much into our days and either end up exhausted or having to cancel. It’s
I’ll leave you with three small things I do that can really make a difference. One – make your bed every morning. Two – set your alarm ten minutes earlier than you need to. When it goes off, don’t get up, just lie still. Three – end your shower with a minute of cold water. Self-care is individual: try different things, find what works for you, and remember that the simplest things are often the
THE COURIER Senior editor: Jenica Davis, Zahra Hanif & Molly Jackson Monday 6th March 2023 Lifestyle 17
Celebrating our community as well as providing information to us and our straight allies
Alice Saunders
It can be easy to forget to take care of yourself - but self-care doesn't have to be as complex as you think
We make so many plans that we wind up trying to cram too much into our days...
Their projects represent the queer identities that often go unseen
Lending money to friends and family shouldn't have to be so complex
Image credit:
Unsplash
Image credit: Zahra "Monet" Hanif
Fashion & Beauty
Olaplex and Hair Loss: What is the truth behind the scandal?
domination.
Hair care holy-grail Olaplex has again come under fire, as dozens of women have alleged that the product causes hair loss. With the company's 2022 infertility scandal still fresh in the minds of its customers, is consumer trust in the brand hanging on a split end?
CNN has reported that nearly 30 women have filed a lawsuit against Olaplex's No.0 to No.9 products. The women claim that the products cause breakage, brittle hair, scalp irritation, and bald spots. I own Olaplex No.3 and know many of my friends swear by the product as it rejuvenates their dyed hair. It is important to note though that Olaplex has never claimed to be a hair-regrowth product - it repairs damaged bonds, but customers certainly never signed up for the opposite!

Read the small print and consult your hairdresser
This is therefore a very worrying claim, made even more surprising as the brand has been propelled to a cult status in the social media haircare world. This makes me question how much we really know about the products we are influenced to buy due to their Instagram and TikTok
Rosemary Oil is a product that has similarly taken over TikTok for its hair re-growth capabilities, but as ever, you need to do your research and make sure you dilute the oil or it can cause more harm than good. Always read the small print and consult your hairdresser before making any drastic routine changes.
Olaplex has never claimed to be a hair-regrowth product
Is there truth behind the claims though? While this is a tricky question to answer, the CEO of Olaplex has fought back stating that these claims are not true and the products do not cause breakage or hair loss. It is hard to know what to believe, but as Olaplex has been around for nearly 10 years and has millions of long-term customers including professional hairdressers, if you are an Olaplex lover don't worry too much. It is recommended however that you use Olaplex before washing, do not leave it in for more than 8 hours and avoid tight buns which may cause hair breakage overnight.
It is totally understandable though that some may now be looking for alternatives. Thankfully, there are many other amazing options:
Revolution Hair Plex 3 Bond Restore Treatmentan amazing drugstore alternative, this product has

rave reviews for its ability to strengthen damaged hair from within. And it is only £10!




Epres Bond Repair Treatment- a single-step treatment that you spray on one to two times per week. You can buy the starter kit for £40 on Amazon.
Sebastian Penetraitt Deep Repair and Strengthening Masque- you only have to leave this mask on for two to three minutes for soft and shiny hair.

HAIRVEST Breakage Strengthening Scalp Serum- a key part of having healthy hair starts from the scalp. This serum is a great alternative, on Beauty Bay for £17.
For healthy hair, sometimes the simple things are most effective. Avoid over-styling, excessive heat, and over-washing. But don't fret! Hair oils, treatments, and masks are here for our benefit. Find what works for you!
Speak Up! Is British fashion not using its voice enough?
Emily Lowes
Fashion
Leading fashion designer of London’s fashion week Jonathan Anderson claims British fashion needs to “step up and say something”, especially given the country is in a state of “paralysis”. Anderson, who has recently hit headlines with the boiler suit he carefully created for Rihanna’s half time show at the Super Bowl which revealed her pregnancy, has raised concerns that he has about the British fashion industry. After names such as McQueen and McCartney have moved to the Paris schedule, this year’s London fashion week line up was left bare.
The death of Dame Vivienne Westwood in December of last year has sent shockwaves through the world of British fashion.
expressive and vibrant fashion trends, which has no doubt impacted the entire fashion world.

So what of the British fashion industry today, and how could the fashion industry revive a nation in paralysis? Anderson‘s concern is that the British fashion industry is not speaking loud enough, and it seems as though he plans to shake it up using
If consumerism of the 70s post-modernism was a neatly set and perfectly laid table, then punk was the D.I.Y gritty hand that grabbed the cloth and pulled it so hard the table was left only shaking. Early British punks used fashion to express an anti-establishment ideology which rejected mainstream cultures and provided a space where at the very centre, was the rule that expression and creativity could not and would not be capped. The punk waves crashed all over the globe, leaving people dripping with a sense of anarchy and liberated expression.
The British fashion industry contributed almost £20 billion to the British economy in 2021
“Westwood was extraordinary – she changed British culture, and it feels like it is only now that we are appreciating the full scale of what she did”, said Anderson. Anderson seems to be taking inspiration from Westwood’s legacy and incorporating it into his own work, with his recent show focusing on anti-establishment messages
Some suggest that punk itself today may have drifted somehow into the land of mainstream and this itself is cause for concern, as today we have a crisis of consumerism, capitalism and political motives which are being pushed from what sometimes feels like all angles. This is the pinnacle point in which British fashion can come in and create big changes. Watch this space, as this is an incredibly
5 Monday 6th March 2023 THE COURIER
18 Sub-editors: Samantha Seidu & Lizzie Yockney
Lyndsey Sleator
is certainly an economically powerful force, but to what degree can generate social change?
This year’s London fashion week line up was left bare
Image credit: Instagram @olaplex
Image credit: Pixabay
Image credit: Instagram @burberry
Image credit: Instagram @evelilycp
Fashion & Beauty

Oxfam’s London Fashion Week Show Spring into these staples
Lucy Reeves
pollution and the amount of clothing existing. As society is becoming more and more aware of this, shopping secondhand in charity shops or online on Depop, Vinted and Ebay has become standard practice - not only is it sustainable but it is cheaper, more exciting and creates a more unique wardrobe.
Last Thursday, Oxfam opened London Fashion Week with a catwalk showing exclusively secondhand fashion, curated by Bay Garnett, huge advocate of thrifting fashion. The show, Fighting Fashion Poverty, was a collaboration between Oxfam and Ebay, the clothes being sourced from Oxfam’s huge warehouse and the looks being later sold on Ebay to raise funds.
The show brought together a range of issues surrounding the fashion industry. It provided a commentary on trends, as Barnett actively rejected styling according to trends and aimed to curate looks which reflect many different fashion styles. Most importantly, it brought the spotlight to the destructive nature of the fashion industry: the high turnover of styles and the emergence of fast fashion. Fashion shows provide a stage for designers to exhibit new designs, new styles and new products. The Oxfam show contradicts this; rather than bringing new designs to the mainstream, it brings a new approach to enter into the world of fashion: reusing and rewearing existing clothes.
The fast fashion industry is one of the most polluting sectors, causing huge amounts of environmental pollution and unnecessary waste, not to mention the human exploitation of workers in sweatshops. In highstreet brands, newer and cheaper styles appear every week, contributing to the unethical production methods, environmental
The Oxfam show at Fashion Week has been an important step to promote these practices, raising awareness of the issue whilst promoting an alternative to buying new. London Fashion Week gives the cause a global stage and places it amongst other luxury high-fashion labels which bring an audience and legitimise the value of this show on the same level as mainstream designers.
limit creativity in the industry. But catwalks are incredibly influential to the world of fast fashion, we see designs on the catwalk and a couple weeks later we see the same thing on the highstreet. Sustainability in the fashion industry relies on the scaling down of fast fashion. A huge impact could be made if high-fashion designers also changed the way they design and present designs.
The variety of celebrities featured on the catwalk further supports and popularises the concept of buying secondhand; their endorsement will have an impact on society and trends around which styles to wear. The inclusion of a catwalk featuring exclusively preowned clothes opens up the idea that other designers could include existing pieces or put more emphasis on reusing and recycling previous clothing in their new designs. That being said, could we imagine a fashion week with exclusively secondhand fashion? It sounds contradictory, as fashion weeks are used to present new collections and inspire new designs. Simply reusing clothes would defeat the point and could
I think that the popularity of secondhand fashion is only growing, social media being a driving force - watching TikTok charity shop hauls is incredibly satisfying and inspires you to go and find some absolute steals. In general society and especially in Gen Z culture, secondhand has become mainstreamcase a very good thing! But putting secondhand fashion in the context of high fashion, luxury brands and emerging international designers enables the idea of sustainability to intercept a different field. Its presence amongst these designers brings the issue of sustainability to the attention of people in this level of fashion, which will have an impact on the industry as a whole.
A guide to second-hand shopping online
a brand or even order some of their clothing to find the right size. When you know your size, you can return it, and then find a heavily discounted version on Vinted. Although, do keep in mind that with pre-loved clothing, and particularly with items like jeans, they do tend to shrink over time.

It’s no secret that the fast fashion world is crippling our climate. Whilst there are loads of small, sustainable clothing businesses, the prices can rarely compete with the monthly flash sales of mainstream, tax-avoiding retailers. If you’re adamant on living more sustainably, secondhand marketplaces like Vinted and Depop are a great ethical option! Secondhand shopping sites like these can be hard to navigate at first and can be very daunting as refunds aren’t an option. As someone who has become familiar with these apps, with Vinted being my new Asos, here are some tips for a successful secondhand shop. Firstly, always like and favourite items that you are interested in. The majority of the time, sellers will see that you have favorited their item and will send you a discount. If not, you will get notified when the seller drops the price of the item that you have favourited. This will also help Vinted and Depop cater to your taste – the algorithm will work out the type of items you are interested in and will recommend more products that are similar to your style. Also, if the seller doesn’t contact you, don’t be afraid to reach out to them! Most sellers will accept offers you request as a lot of them are more concerned with getting rid of the item rather than how much they can get for it. The same applies for requesting bundles! Pay particular attention to how old the listing is – if there is an item you like that has been up for quite a while, the seller is more likely to accept a lower offer.
The final fear of shopping on secondhand marketplaces is getting scammed or ripped off. The likelihood that this will happen to you is very rare, but always check the reviews. An indicator of a good seller is if they have a lot of pictures of the item from multiple angles, making it clear that they are not hiding anything. Transparency is key, therefore sellers who openly draw attention in their pictures and description to a stain on the item, or if they mention that it runs smaller than the size that the label says are generally trustworthy. Always check the descriptions of items too; I often find that if the seller stresses that it’s vintage, and spams the description with #y2k or #fairycore, then they are usually exploiting a current trend and aesthetic, raising the price to much higher than it’s worth.
My last tip is to trust middle-aged mums! Not to stereotype too much, but I’ve always had the best experience buying from them as they have been the most informative and genuine sellers that I’ve interacted with on Vinted.

Happy second-hand shopping!
 Imogen Smillie - TV Sub-Editor
Imogen Smillie - TV Sub-Editor
Getting the sizing right is another aspect of secondhand shopping that puts most people off. My tip is, if you’re unfamiliar with the brand of a certain item you like, try to go into the store of

t’s time. The clouds are fluffier, the birds are chirpier and there’s only a few less rainy days, which can only mean that spring has sprung! But in this awkward transition period from winter to summer, what are some favourite spring staples – the must haves of the season, if you will.
My personal essential for this time of year is any type of shacket. Not quite a shirt, but not quite a jacket, the humble shacket gives you just a bit more warmth than a shirt, but not as hefty as a jacket. Perfect for those days when you leave the house first thing freezing cold and end the day a sweaty mess. A variation and yet another stylish favourite is the combination of oversized denim jacket and hoody. Take your favourite, comfy hoody and stick any colour denim jacket over-the-top, and you’ve got the perfect cover up for sunny days that have a chill in the air (maybe just remember your umbrella
Now that the weather is looking up, maybe it’s time to put the jeans away and swap them for a lighter option. In a similar style to the on-trend baggy mom jeans, there are plenty of cotton and linen variants to stay cool in, just as the sun is coming out again. Dress them down with a hoody or shacket (yes I’m a little obsessed) or dress them up in co-ord style with a matching blazer jacket. You’ve probably already got a pair in the cupboard – I’ve seen plenty of you donning these on And as always, a trusty pair of high top Converse can sort you out in all weather


THE COURIER Sub-editors: Samantha Seidu & Lizzie Yockney Monday 6th March 2023
19
Most importantly, it brought the spotlight to the destructive nature of the fashion industry
Second-hand social media apps are perfect alternatives to fast fashion, but where to start?
If they are exploiting a current trend or aesthetic, they will usually raise the price
As we enter a seasonal transition period, which are notoriously difficult to dress for, here are some spring staples
An indicator of a good seller is if they have a lot of pictures of the item from multiple angles
Perfect for those days when you leave the freezing cold and end the day a sweaty mess
Jenica Davies - Lifestyle Sub-Editor
Image credit: Pixabay Image credit: Instagram @vinted Image credit: Instagram @ebay_uk Image credit: mel.amartinez Image credit: Instagram @depop Image credit: Pixabay
With London Fashion Week being opened with secondhand clothes, we could be entering a new era of sustainable fashion
Travel 20
Travel disasters: the one with phone update
Jessica Mckeown - Film sub-editor
Ever been in an unfamiliar city with no access to maps, money or phone numbers?
Solo travelling has been one of my biggest achievements to date. Sick of waiting for my friends to be available and actually have the money, I spontaneously booked a trip last year following the end of first year. However, there was a little hiccup half-way through my week away.
My first destination was London, hopping on an early morning Lumo train to King's Cross. Staying at a hostel in Camden, I explored the British Museum, ZSL Zoo and watched Grease: The Musical at the theatre. I then got an early morning Eurostar to Amsterdam, where I spent my first afternoon bed bound thanks to motion sickness. My first full day in Amsterdam took me to the Jewish History Museum.
From the start of this trip I had been lucky, finding a train from Newcastle to London for just £20. I even found a five pound note that had been dropped outside St Pancras station. Of course, inevitably something was going to go wrong. On my second day in Amsterdam, my phone decided to do a system update.
To my horror, the phone would not turn on after. Whilst I had printed off all relevant tickets, I didn't feel comfortable heading to Berlin the following day without a working phone. No access to maps, no contact with my family and worst of all, the PIN to my parents' travel card were all sealed off from me. Panicking, I used what was left of my euros to purchase a Eurostar ticket for the next morning. Needless to say, I was fuming when my phone turned back on at 11pm. Fortunately, my parents encouraged me to continue on to Berlin (which I enjoyed enormously).
Will I let that stressful day put me off? No, but I would like to return to Amsterdam and Berlin with my sister.
On another note, because I was travelling alone and hadn't properly spoken to anyone, I sounded absolutely awful by the time I was checking into my hostel in Berlin.
Ticket to ride: scenic European train rides
Memoona Afzal
Take the train to see Europe a different way this summer!
Europe is blessed with numerous breathtaking natural spots, with visiting Europe making it onto many people's bucket list every year. What about having a look at some of these stunning views all the while you are aboard a train? Trains promise to give you a peek of many a European attraction.
Bernina Express, Switzerland

One of the most scenic rides in Europe, giving you stunning and sweeping views of huge mountains, placid lakes and green valleys. It runs between Chur, a town of Switzerland to Tirano, Italy. Usually, it takes 4 hours to cover this 90-mile memorable journey. It costs around 160 pounds for the first class. It does not matter, if you are a spring lover or a fan of snow this ride holds spectacular promises the whole year. This UNESCO listed train takes you through 55 tunnels and 196 bridges and has 25 stops. Hop on it, and the train will take you along the Alps with its panoramic glass windows. Other than the Bernina Express, The Glacier Express, Golden Pass Line, West Highland Line are also other famous train rides through quaint Swiss Villages and dramatic mountain landscapes.
Image credit: @berninaexpress.ch
Simplon-Orient Express
Were are the fans of Agatha Christie? They might know about it more than any other traveller because of the Murder on the Orient Express, the novel turned big hit movie. Starting from London Victoria Station and ending near the Grand Canal of Central Venice, this train ride offers a once in a lifetime experience in more than one way. Its vintage carriages, world-class dining, piano bar lounges along with the wonderful Alpine scenery makes it more alluring among all other train rides of Europe. Those who have travelled in it, believe that this journey, that costs 3300 pounds for a solo traveller, exceeds all expectations. You will get the glimpses of astounding beauty of the European cities like Paris, Florence, Vienna, Padua, Milan, Amsterdam, Brussels, Budapest just in 24 hours ride.
El Transcantábrico, Spain
Ever fancied a five-star hotel amidst luxurious beauty of nature? If your answer is yes then a ride on El Transcantábrico is a must for you. Takes you through the Northern Spain that is known as the picturesque part of Europe. From the historical Altamira cave, marvelously preserved medieval town of Santillana del Mar to the national monument of El Capricho, an architectural masterpiece of Gaudi alongside other spectacular sights promised during this ride. Multi course dining, exquisite night-life, sensual spas along with wood panelled lounges and suits are irresistible additions of this European extravaganza of a ride.
The Caledonian Sleeper, UK
Why do we always have to choose between sunny or snowy? Why not have an experience of nocturnal magic that reaches it peak when the moon is high? This train between London to Scotland offers an overnight journey along with all the famous scenic Scottish spots. Moreover, to enrich your experience with luxury, different accommodation options are available ranging from ensuites to the classic room, traditional Scottish breakfast is offered in the club car. Besides, not only you but your pets are also welcome. This journey of stunning views of lochs, mountains and moors of Scotland is bound to be a memorable memory for its riders. The West Highland Line also travels through the iconic Glenfinnan Viaduct famous among all Harry Potter fans.
The Settle to Carlisle Railway

In the UK, this line is one of the last great mainline railways, built in 1876. It offers a picturesque 72 miles ride of English green fields. It includes views of Eden valley, Lakeland Fells, Three Peaks and quarter mile long viaduct of Ribblehead famous for photographers. On the train, your journey becomes more informative and exciting with five high mounted cameras so that you do not miss any spot of breathtaking scenery.
After riding these iconic scenic trains you will understand why it is said that it is not the destination that matters but the journey!
YouTubers and bloggers that inspire us to travel
Charlie Reid
In need of some inspiration? Use social media to find tips for your next travels!
Due to the prevalence of social media surging since the early noughties, access to online travel content and inspiration has never been more opportune.
Online platforms like YouTube and Instagram are highly favoured when it comes to finding travel content. Offering a generous portfolio of content creators each with their own travel style and niche, it can be difficult to gauge whether a creator's advice and tips are reliable. Using my own experience of trawling the internet for different creators and travel bloggers, here are my recommendations.
Solo female backpacker and YouTube content creator Christianne Risman, more notably known as ‘Backpacking Bananas’, has amassed over 180,000 subscribers on YouTube, where she shares all her best top tips and tricks for fellow backpackers planning their next adventure.
For individuals eager to get out and meet people whilst travelling, but don’t want to go at

it alone, Risman has hosted a range of group trips, recent ones included a two-week journey through Pakistan, and a scuba diving retreat in the Thai islands, notorious for great diving in the Andaman Sea.
Assembling a plan and route for a trip away can be daunting as time and budget are factors weighing heavily on how you spend your time away. ‘The Broke Backpacker’, a website run by a team of travel-crazy friends share extensive tips, tricks and information ranging from the best transport links to offering useful words for travellers to pick up, depending on the language. The website also suggests different routes to follow on your adventure, depending on your time constraints, offering tips for all travellers.
If you and your partner are planning an adventure together, finding content creators who travel as a couple is a good way to stay informed about different countries' and cultures' rules on travelling as a pair. ‘Along Dusty Roads’, is a travel blog run by couple Emily & Andrew, who share their best tips and advice for couples (and singles!) who want to hit the road together.
Relatively new to the travel contentcreating scene is Kate, owner of the
Instagram account ’Masked Travels’, which started during the COVID-19 pandemic, sharing the best tips on COVID-affected travel.

Two years on Kate has quit her job in the city and works fully online for a range of travel companies, as well as her own Instagram account which has over 10,000 followers, where you can find in-depth, valuable tips and advice for travellers. Kate is also a solo female traveller, who has taken on the likes of Mexico and Colombia alone, showing other travellers how easy it is to make friends the moment you set foot off the plane.
For those of you with sea legs and a keen appreciation for sailing, ‘UnTide’ is an account which has platforms on multiple sites including Instagram, TikTok, and Youtube as well as their own blog.

Hailing all the way from Cornwall, boat skipper Max has documented his nautical escapades on board the Elixir, which has sailed from sleepy Portsmouth across the Atlantic, Caribbean, and into the Pacific Ocean. Whilst sailing around the world Max picks up fellow travellers keen to sail and help out on board what can only be described as a floating hostel.
With a variety of different social media platforms at your disposal, you’ll be in good hands when planning your next trip.
5 THE COURIER
Sub-editors: Jude Parkinson, Ellen Pinch & Elžbieta Voverytė
Image credit: @UnTide on Instagram
Image credit: @ MaskedTravelsx on Instagram
Monday 6th March 2023
Image credit: Pixabay
Budget-friendly travelling
Emma Hunter
cheapest alternative for your mode of transport –you don’t need me to tell you to go for, say, Ryanair over KLM. Travel and wait times also need to be taken into consideration; unfortunately, the more inconvenient (such as very early morning departures), the cheaper.

If you’re dreaming of a chance to discover a new place and escape uni pressure, but are put off by the towering costs of holidays, it might be time to reconsider the way you think about travel. Holidays will inevitably involve spending extra money, but with the right approach it’s possible to keep expenses to a minimum.
With traveling, the trick is to think logically: break down the trip into four aspects and consider each one in terms of a budget continuum. The first and most important aspect is location. As a general rule, the more popular, bigger and wealthier a destination is, the more expensive it will be to get to, stay in, and eat there. For the budget end of the scale, think lesser known countries and smaller towns and villages within them. Make sure to do your research – those clichéd ‘hidden gems’ you hear about do actually exist, often near their more famous equivalents, if you know where to look.
Solo travel top picks
 Carly Horne - Head of Culture
Carly Horne - Head of Culture
Luckily, what I consider the most exciting part of travel – exploring new places – is completely free. I love to walk and walk and walk around a new city, soaking in all the sights, until my feet drop off. You can rest at home in a place you know already. Maybe I’ll throw in the odd bit of window shopping and reading on a park bench. If you’re not careful though, the cost of your holiday activities can add up too. Food can be kept very basic if you only buy essentials at a supermarket, but it’s also important to try some local specialities – a quick google search on where to find the most affordable version should help you. Sometimes you’ll have to forego buying entry to things like attractions, famous monuments and museums and just be content to see it from the outside – simply being there is good enough.
A final thought, which for me is the most difficult, is planning. The further in advance you book, the lower the prices will be. You’ll be able to book the cheaper slots before they get snatched up. So if you fancy a budget-friendly break this summer, get researching now. In any case, it’ll be a good distraction from the mound of uni work you’re trying to run away from. All the continuums considered, it’s now a case of selecting the cheapest option you feel comfortable with. The hard truth is that you will need to make to make your trip
Once you know where you’re going, you’re going to need a place to stay. The accommodation continuum will always have hostels, Airbnbs, and even campsites on its budget end – booking.com and hostelworld.com are some easy sites to find and compare. Prices will of course vary depending on conveniences such as privacy, services, comfort and quality, as well as travel connections and proximity to attractions. Be warned that though smaller towns and cities tend to be cheaper, smaller destinations will have less of a range of accommodation options, including budget ones. The third sliding scale is really important for trips and can have a significant impact on overall cost: transport. Affordable options tend to be coaches, flights and sometimes trains – again though, location plays a big part in this. Normally it is cheaper to travel less far and to lesser known places, but not necessarily. Make sure to choose the

Travel photo of the week

Best place for plane spotting in the UK
It is without a doubt that the most exciting airport in the UK is Heathrow. The size of a small city, Heathrow sees over 1,000 planes depart and arrive each day; making it the ideal place for plane spotting. But with a constant stream of planes in the sky- where is the best place to see them? Possibly the most iconic spot for plane spotting here is Myrtle Avenue in Hounslow, a five-minute walk from Hatton tube station. This piece of grassland sees planes land so close to Heathrow that it feels as if you can touch them yourself! Here you can see planes landing from Heathrow’s Southern runway and taking off from the Northern runway, so there is
plenty of variety. From the classic superjumbo A30 to the new Airbus A350, spectators can see planes of all sizes, landing from all over the world. If you prefer a space with more facilities, Heathrow Academy is the ideal location for a family-friendly, plane spotting day. Located on North Perimeter Road, there is a covered viewing stand which is always free of charge. Inside the academy there a café and an aviation-themed gift shop, making it the perfect spot for an affordable day out. Here you can view planes parked at Terminals 1 and 3, with a fantastic view of the runway 27R. If you are lucky enough to be flying from Heathrow, Terminal 4’s observation deck has a 270-degree view of
Solo travel has increased in popularity in recent years - and rightly so! Here are my top recommendations of places to explore if you want to see the world solo.

Glasgow, Scotland
If you're unbothered by a little bit of rain, Glasgow could be the perfect place to visit - especially if it's your first time exploring solo. Not only is there much to see in Scotland's largest city, but if you find yourself looking to explore beyond Glasgow there are reliable and affordable transport links to Edinburgh and the North.
Glasgow is host to a lively music scene, multiple art galleries and a wide range of food to choose from. The people are friendly, the city is diverse and accommodation is generally affordable and well-located. While Glasgow is generally safe, travellers should exercise the same cautions they would in any other big city.
Barcelona, Spain
Barcelona is one of the most beautiful cities in the world (in my opinion), with iconic architecture and a vibrant, friendly vibe all around. La Rambla is a must visit area (certainly very tourist friendly) and Plaća Reial offering up a range of options for restaurants and cafes. With more cathedrals, markets and bars than time to explore, Barcelona is a fabulous option for those looking for a little bit of sunshine and culture.
New York City, United States of America

This might seem an odd pick, but having visited New York City twice as a solo traveller, I can say it's one of the places I have felt safest going solo. One of the more obvious perks of visiting the Big Apple is that there will always be people around in the tourist areas, and consequently, these areas feature a heavy police presence.
But there is so much to do in New York, beyond the more obvious attractions (Statue of Liberty and the Empire State Building, for example).

My only real concern when I'm in New York City is the subway, which I'd just exercise a little more vigilance on when alone. Do your own research, but the City That Never Sleeps is a must-see and an excellent choice for travelling solo. My favourite hotels to stay in are the Dream Hotel Midtown, OYO Times Square and the Moxy NYC Chelsea.
Nice, France/ Monaco
Nice is home to the Promenade des Anglais, a seven km promenade along the Mediterranean coast of the city. Additionally, the Cathédrale Saint-Nicolas de Nice is a beautiful site of religious architecture and Musée d'art moderne et d'art contemporain (MAMAC) is a must visit for fans of contemporary art.
The drive through Beaulieu-sur-Mer and Èze is stunning and the arrival into Monaco is no different. Monaco-Ville and Monte Carlo are my top picks with fantastic restaurants to choose from and plenty to do
London, England
London is easily my favourite city in the world and is a great place to visit to ease yourself into solo travel. I've lost count of the number of times I've visited on my own, and thus, I can wholeheartedly recommend taking a trip to England's capital.
THE COURIER Sub-editors: Jude Parkinson, Ellen Pinch & Elžbieta Voverytė
21
Travel
Neve Stillito
Holidays will inevitably involve spending extra money, but with the right approach it's possible to keep expenses low
Travelling doesn't have to break the bank, here's how you can make your money and time abroad last longer.
Image credit: Pixabay
Ollie Withers
"Taken in the Kruger National Park, South Africa. A juvenile giraffe sticks its tongue out at the camera whilst grazing."
Image credit: Ollie Withers
Image credit: Pixabay
Monday 6th March 2023
Image credit: Pixabay
Food & Drink
Kitchen stereotypes: housewives vs. chefs
Sarah Thompson
The idea of the housewife was seemingly eradicated through the industrial revolution and world wars, as women entered the world of paid labour. This is untrue. This character of the housewife was simply repackaged.
When we look at the figure that only 17% of professional chefs in the UK are women, it is clear that the prescribed dominance women had in the sphere of domestic cooking has not translated over to the professional scene.
we must turn to the underpinning sexist culture. Cooking is an ability traditionally aligned with femininity - however, when cookery became economically exploitable, it blurred into the realm of the traditionally masculine ‘producer’ role. When women are good at cookery, it is not praised, but seen as part of a woman’s intrinsic nurturing ‘nature’. Alternatively, men are applauded for the development of a ‘skill’.

This translates into professional kitchens, as we unconsciously applaud men for their skill developmentwhich we intrinsically link as more worthy of economic reward, than a female chef whose ‘nature’ is more suited to cookery Professional kitchens run on schedules that are incompatible with the prescribed domestic duties of many women (e.g. busy shifts are in the evenings and on school holidays).
Our culture still deems women as the primary caregivers, a role that is often used in arguments against women’s competence to have simultaneously successful careers and families.
reported being mistaken for assistants. This once again undermines female autonomy and capability. To work in a professional kitchen is a universally demanding role. However, working
physical labour, but also the necessity to consistently prove yourself capable against a culture that consistently looks to deny this.
Widely cited as a reason for this is the labourintensive environment of professional kitchens. Male chefs are labelled as ‘consistent’ and ‘innovative’, supposed skills that make them better suited for professional kitchens. However, to view this gender imbalance as a lack of personal competence is a gross misunderstanding. Instead,

Additionally, professional kitchen environments have been accused of many instances of inappropriate comments and touching. Female head chefs have


Fabulous female-owned eateries across The Toon
I-Fen Yang
Celebrate International Women's Day on the 8th of March by visiting some of these female-owned
With International Women's Day coming up, we are exploring some femaleowned eateries around the North-East. There are many very good restaurants created by incredible women. Here is a snippet of some of them:
Veganatomy:
Veganatomy is Asian fusion cuisine created by Zoë Newman. Their sushi is the first and only 100% vegan sushi in Newcastle. Zoë Newman started her creative culinary art in 2020, and she is not only a chef, but also an anatomy illustrator which is the reason for her brand “Veganatomy”.

Zoe Newman started her creative culinary art in 2020
Veganatomy just finished their pop up at The Salt Market Social in North Shields and their resident stall is reopening at By The River Brew Co on 3rd March with a brand new menu!
before ordering this one. Also, the Thai milk tea is a good appetizer, it is brewed by tea leaves and has a combination of bitter & sweet tastes and scents; it’s a unique Thai drink! In the restaurant, they have enough seats for walk-in customers and the staff are very efficient. If you want to try Thai food, I would definitely recommend Thai house café, but be aware this is cash only.
Shijo:
Shijo is a Japanese street food café serving Japanese hot and cold dishes. They use the freshest local ingredients and do not use any MSG, artificial colours, or preservatives. If you have never been to Shijo before, I recommend its Chicken katsu curry donburi! The chicken katsu mix is serveded on steamed rice; it’s very tasty! If you want to try some smaller food, I recommend Takoyaki and the spring rolls. They are well fried and crispy! Shijo is located in a very good spot, just right outside of the Haymarket metro station, next to the Northumberland Street and opposite the INTO Newcastle university. If you are a student, or just shopping around the street, taste this Japanese street food! I bet you will be satisfied.

5 THE COURIER
22 Sub-editors: Daisy Harrison, Katy McEwan & Abigail Roch
The intersectionality between femininity, masculinity and cooking.
When women are good at cookery, it is not praised, but seen as part of a woman’s intrinsic nurturing
Image credit: Pixabay
Image credit: Pixabay
Image credit: Instagram @veganatomy_uk
Monday 6th March 2023
International Women's Day 2023: celebrating female chefs
Carly Horne ~ Head of Culture
Getting to know some of the most impressive female chefs
Though most recognisable for her time on The Great British Bake Off, Mary Berry is an incredibly accomplished woman exclusive of the BBC hit. GBBO is as much a comfort programme as the rest of her resume, including my personal favourite, Mary Berry's Easter Feast.
cookery books, I can confirm that her only agenda is to share her joy of food and to show that preparing nice food doesn't equate to hours spent in the kitchen. Much like the feel of the show, her books provide a variety of recipes - from no-fuss, comfort food to more adventurous treats for the more skilled baker.
Mary Berry has long-provided a different kind of cookery show than many of her counterparts. Where some chefs and bakers are aggressive in affect, she is softly spoken and kind. Where some are keen to display the most complicated of recipes, Mary Berry's are accessible for even the greenest of home bakers.

As someone sent off to university with one of her
Her life has also been incredibly interesting, from time spent in France to having to overcome personal adversity. Religion has long played an important part in her life, and her family too holds an important place in her heart. Her Desert Island Discs episode is well worth a listen as she gives viewers an incredible insight into her life and career.
The Ultimate Pie Showdown: sweet treats or savoury delights?
Annie- Rose Edwards
The answer to the age old debate - which pie reigns supreme?
British Pie Week means it's time to settle the age old debate of which baked beauty does it best - sweet or savoury?
The electric light bulb, the telephone, the World Wide Web…. whilst they all may well be great inventions, there’s no denying the likes of mince pies or a steak and ale number are actually some of Britain’s finest creations.
There's only one sweet pie that gives
We might all be able to agree that pies are the crème de la crème of the British food scene, but one important debate remains unsolved. Last week, on Pancake Day, a burning question divided households across the nation, and now we're bringing it back, this time, about beautiful British pies. So, should they be sweet or savoury?
For me, there really is no debate to be had - savoury pies do it best, hands down. Whether it’s a homemade Cottage Pie that takes you straight back to your childhood and going round to a friend's for tea, a pork pie fresh from the local butchers that every British Grandad
lives off, or just a hearty pub lunch of chicken and mushroom pie with lashings of gravy after a long walk, the savoury pie is most certainly versatile and delicious, without fail.
There’s only one sweet pie that gives its savoury counterparts a good run for their money, and that’s the mince pie. Whilst words like mincemeat and suet don’t exactly scream “fine cuisine” to most people, there really is no denying that the very first bite of a homemade mince pie, fresh out the oven and filled with rich fruity goodness marks the start of the cosy winter season and never fails to get everyone well and truly in the Christmas spirit.

So, whilst I'm
to the odd sweet pie when they make their brief, but welcome appearance over winter, it’s safe to say that savoury pies hold a special place in my heart, and definitely take the well-deserved title of best type of pie. To anyone out there who says British food isn’t much good in comparison to other tasty dishes on the international scene –you really will be eating humble pie when you take your first bite of a steak and ale pie, with chips and gravy, in front of a roaring log fire at the pub. Just try and convince me otherwise.
chefs
The excellence of female
Women who are at the top of their culinary game
Prue Leith
Firstly we have TV personality Prue Leith, a South African born chef, restaurant owner, caterer, as well a novelist and broadcast journalist. Leith has produced 12 cookbooks and became a Dame last summer, due to her contributions to food, television and charity.
Minette Bridget Hill
Minette Bridget Hill is a British farmer who runs a catering business in Wiltshire. She has recently made history as the first female President for the National Farmers Union of England and Wales! She is currently trying to face the issue of food security for the UK, following the decision to leave the EU.
Clare Smyth
Clare Smyth changed history in 2017, as she was the first British female chef to run a restaurant with three Michelin stars, even achieving a perfect score in the Goof Food guide.
Cristea Comerford
Cristea Comerford was the first woman, Filipino-American, and Asian to be selected as the White House Executive Chef. She was appointed by President Clinton in 2005, and asked to stay on during Obama’s run as president.
Nadiya Hussain
Nadiya Hussain is a celebrity chef after winning Great British Bake Off. Hussain has been given an MBE and named on BBC’s 100 women list.
Asma Khan
Owner of the Darjeeling Express, Asma Khan has gone on to challenge the stigma of second daughters in Indian families. Despite achieving a law degree and a doctorate in British Constitutional Law from King's College London, Khan knew her future lay in the food industry and began supper clubs. Starting with a residency and later winning her own restaurant, Khan's restaurant is entirely staffed by women, most of whom are immigrants and/or second daughters. Khan became the first British chef to appear on Netflix's Chef's Table and started up the Second Daughters Fund, which is a non-profit.
Ruth Hansom:
At age thirteen, Ruth Hansom began growing fruit and vegetables in her mother's garden, sparking an interest in cooking that took her to the position of runner-up in the Future Chef competition at age sixteen. Attending Westminster College, Hansom jumped in the deep end with a three-year apprenticeship at The Ritz, being trained by execute chef John Williams MBE. Working her way up to the position of chef de partie, the restaurant was awarded a Michelin star on Hansom's 21st birthday. She took part, won many competitions, and achieved her first head chef position at the Luton Hoo Hotel. After the Hotel shut down, Hansom moved to The Princess of Shoreditch gastropub where she won many accolades, including three AA rosettes. Hansom can now be found as executive chef at the Swinton Estate.

THE COURIER Sub-editors:
McEwan & Abigail Roch
23
Daisy Harrison, Katy
Food & Drink
its savoury counterparts a run for their money
Image credit: pixabay
Where some chefs and bakers are aggressive in affect, she is softly spoken and kind
Jessica McKeown ~ Film Sub-Editor
Image credit: Facebook - Mary Berry the Cook
Sarah Castledine
Monday 6th March 2023
Lucy Bower & Rowan Christina Driver
Desire, I Want to Turn Into You
Caroline Polachek
Lorna Bristow
Caroline
Easy Life: Leicester's prized indie pop

Caroline Polachek's sophomore album, Desire, I Want To Turn Into You, was released February 14th 2023, a fitting day to release an album following topics of desire, love and introspective self-discovery. The album paints a journey of embracing emotions previously held back, portrayed through energetic and warm melodies. While this is her second album under Caroline Polachek, and so it’d be an easy mistake to brand her as a new artist, she has years of experience behind her, formerly a part of indie pop duo Chairlif, releasing an electronica album under Ramona Lisa and venturing into instrumental sounds under 'CEP'. Alongside this, Polachek has written for artists like Beyonce, Travis Scott, Flume and Charli XCX. These years of building, curating a sound, and maturing are all evident in this album.
Consisting of 10 tracks, Polachek paints themes of escapism, love and, of course, desire. A personal favourite is the opening track 'Welcome To My Island', Caroline perfectly uses her vocals, with a catchy 'hey hey hey hey' motif, accompanied by a stunning guitar solo and synths that make the track slot together. I strongly suggest checking out the music video too. The Harle-produced track, 'Bunny Is A Rider' stands out too. With whimsical delivery and an instantly recognizable whistle feat, alongside lyrics that don’t entirely make sense, a running theme throughout Caroline's work.
Next, tracks 'I Believe' and 'Crude Drawing
Of An Angel' showcase Polachek's ethereal, magnificent and confident vocals. Her voice dominates these tracks, making the tracks seem both inviting and personal. 'I Believe' is about immortality, and was dedicated to the late visionary SOPHIE, with Caroline saying “it wanted to feel like thinking, like sailing, but also to feel physical, warm, full of heart” using her voice, which is definitely prevalent here. This amount of emotion carried by Caroline's vocal continues throughout the record. Overall, this is a monumental alternative pop album, and a career-defining moment for Caroline. Paying homage to underappreciated, yet pioneering artist SOPHIE, while overcoming the fate pop albums often fall into of fearing pushing boundaries, stuck in a loop of producing something catchy, but not long-lasting.
Many pop albums can feel predictable and one dimensional, something that means I typically tend to stray away from pop albums, but Caroline defies all the above. At no point throughout listening did I feel it was repetitive, or could I predict turns like the implementation of drum and bass and Didos feature on 'Fly To You'.
Caroline shows her dynamic ability in both her vocals and production, and a uniqueness not seen very often. There are influences of alternative sounds from the 70s and 80s, as well as modern elements of hyperpop. This may be why many critics declare Polachek Gen Z’s Kate Bush, but while it is a compliment, Caroline Polachek may be building a sound that doesn’t need comparisons, but to hold value as herself, not compared. It's safe to say, just two months into the year, this album has secured a spot, at least for me, for one of the top experimental pop albums of 2023.
Easy Life are a difficult band to introduce due to their wide range of music placing their songs into several different genres. But the genre they fall mainly into would be indie pop due to a blend of their alternative lyrics and easy to listen to beats creating a slightly mainstream sound whilst also remaining unique to any other band.
They released their first hit single ‘Pockets’ back in 2017 which would later go on to be put into the FIFA 19 soundtrack and would become an earworm for all FIFA players due to the catchiness of the songs chorus. This song remains to be one of the bands biggest all-time hits as it stands in 3rd place for their most listened to song on Spotify with over 20 million listens.

The band only released singles and mixtapes at the start of their musical journey and had many hits such as their soft romantic tune ‘Sangria’, the story of the lead singers heartache with ‘Frank’ and the catchy melody of ‘Peanut Butter’. However, the Leicester born group truly took off with the release of their first official album life’s a beach which features their most popular song ‘Nightmares’ whilst including other big hits like ‘Ocean View’ and ‘Skeletons’.
The release of this album resulted in Easy Life
being invited to perform their new songs at BBC Radio One’s Big Weekend, which brought eyes towards the tuneful style of the band as well as to their charismatic lead singer Murray Matravers.
Their latest album Maybe in Another Life provided various contrasting and creative songs within it, ranging from a club type song in ‘Basement’ to a more soulful and emotional piece with ‘Moral Support’, which again exhibited their variety in song making capabilities.

The city of Leicester has had a short supply of noticeable bands apart from the likes of Kasabian, therefore this recent upsurge in support for Easy Life will surely raise spirits and morale whilst also possibly inspiring other upcoming artists to follow in the footsteps of the rapidly growing musical group.
As the bands popularity continues to increase, it seems inevitable that they will become one of the UK’s biggest artists within the next few years and as
they poetically put it, their unique selling point is that they are "completely lame", this modesty will be bound to attract copious amounts of fans.
The Soundtrack of the BAFTAS











All Quiet on the Western Front’s BAFTA winning soundtrack does a fantastic job of setting the tone of the movie. By combing classical elements with harsh electronics, it emphasises the horrors witnessed by soldiers on the front line of modern warfare.
On its way to becoming the biggest winner at this year’s awards season, All Quiet on the Western Front has already picked up several accolades, including for its score. The music uses an intense fusion of violins, cellos, and brass instruments in tandem with highly textured, modulating electronics which creates a moody soundscape reminiscent of the sodden battlegrounds of No-Man’s Land. The use of classical instrumentation reflects the music of the early 1910s, but by incorporating electronics, it mimics the advent of new

The track “Tanks” is the best example of how instrumentation is used to portray the emotions of the soldiers as well as the atmosphere. The piece starts on a menacing drumbeat, suggesting that something dangerous is in the distance, getting closer as the dynamics increase. At the 40 second mark, a large electronic noise is played, followed by the main motif and a marching beat; tanks are moving towards the front line. Electronics are much more aggressive in tone than the strings, I believe the electronics represent the terrifying new machinery on the battlefield, whilst the acoustic instruments are used to portray the naivety of the soldiers. In times of crisis, violins arpeggiate and cellos play with higher intensity. In the final track, the two musical families are battling for the attention of the listener, as the main motif is played on strings in your left ear, while louder electronics play into your right ear.
technology never seen in war.
The soundtrack makes use of a three-note motif, which makes its debut appearance on the first track “Remains”. The motif sounds synthesized but is played on an older instrument called a harmonium. At the beginning of the track, the motif is repeated every 15 seconds, but this cycle shifts to 9 seconds upon its final repetition. The shortening of the interval happens alongside increasing dynamics. Tension is built up until the final repeat, after which, the piece settles to a more minimal style. The structuring mimics the emotion of the film, which begins calmer, reaches a fever pitch at its climax, and ends in a more emotional, quiet way.
Western Front’s soundtrack works wonders in the context of the movie. Whilst not my favourite score of 2022, it does a fantastic job of capturing the emotions of soldiers on the front line, even when listened to independently of its

5 Monday 6th March 2023 THE COURIER Music 24
Sub-editors:
Polachek releases an experimental album that breaks boundaries.....
Lewis Hallett
Image credit: Spotify
By combining classical elements with harsh electronics it emphasises the horrors witnessed
The structuring of the music mimics the emotion of the film
Image credit: BAFTA on Facebook, Pixabay
It seems inevitable that they will become one of the UK's biggest artists
Image credit:Easy Life on Facebook
Adam Symes
Live Review: The 1975 (Utilita Arena, Newcastle)
Amana Khan - News sub-editor
Although previously having seen the 1975 in concert before, their 2023 UK tour was not something that I could have anticipated. Their ‘At Their Very Best’ tour was popularised all over social media and their first London concert brought much excitement for their future concerts after they brought out Taylor Swift.
After being formed in 2002, their popularity has only grown, and their albums have gone from strength to strength. Matty Healy’s eccentric presence on stage is always a crowd pleaser and their performance in Newcastle, on their most recent tour, did not disappoint.


Opening their show with 'The 1975' from their most recent album set the stage up for an exciting performance. They continued give us their best theatrics, which was enhanced by Matty eating a raw steak and trying to sexually arouse the audience.
I was hoping for the band to provide us with a guest act, and they did not let me down. They initially introduced Tim Healey, Matty’s dad, who, surprisingly, gave us an incredibly emotional performance of 'All I Need to Hear'. However, this was not the last of the surprise guest performances and once the lights went dark all I could hear was
the crowd screaming as we thought that Harry Styles was coming out to perform. Though it was Lewis Capaldi, not Harry, the performance did not disappoint, with Lewis performing his newest unreleased single.
What I particularly enjoyed about this concert was Matty’s monologues and his inherent ability to coerce the crowd with his charisma. However, my favourite bit, as with all the 1975 concerts that I have been to, is the broad range of songs that they play across all their albums. The ability for the lyrics of their songs to be engrained in the minds of their fans is frightening, but also shows the ways in which their lyrics mean something of great magnitude. From "I hate to think about you with somebody else", which illuminates the consequences of heartbreak, to “But your death won’t it won’t happen to you”,
Live Review: Loyle Carner
It is safe to say, we are both still mesmerised by the beauty of Loyle Carner on Thursday. Personal, honest, and intimate, his performance had us both tearful and joyful for life, inspired for the future whilst totally immersed in the beauty of the moment.
The 28-year-old from South London employs a style of performance somewhere between hiphop, rap and jazz. His new album Hugo, released in October 2022, gave us high expectations for the night but we certainly were not disappointed.
personal anecdotes to assure people they are not alone. After performing 'Still', an upbeat tune with serious lyrics, he mentioned fearing to release the track but being convinced it could help at least one of his listeners. Men's mental health is something that we should talk more about and music is an integral medium for this.
progression and just being a kinder person, Carner has so many values we can all take forward with us. This is a line and a night we will never forgetThank you.
Cracker Island Gorillaz
Martha Lilli Probert

Gorillaz continue to release their electronic goodness....
On the eve of their debut album’s twentieth anniversary, Gorillaz remain a leading light in alternative electronica. But does Cracker Island live up to the anticipation?
Cracker Island features many of the hallmarks one would expect to find on a Gorillaz album: varied high-profile collaborations, an overarching storyline (though one that feels more subtle than those on some of their previous seven albums), and a solid set of electronic grooves.

Highlights include their collaboration with global superstar Bad Bunny, ‘Tormenta’, which finds a nuanced balance between incorporating Bad Bunny’s reggaeton style into the album’s overall sound and establishing itself as a stylistically standout track. The following track, ‘Skinny Ape’, returns to a much more typical Gorillaz sound, journeying from the soft guitar and ethereal vocals of its opening bars, to an anarchic, high-tempo second half, and all the way back to its lullaby-esque end, which neatly mirrors the conclusion to ‘Tormenta’.

Gorillaz remain a leading light in alternative electronica
The first act of the night was Wesley Joseph who set the tone for the evening and shared the passion of Carner's lyricism with songs that also constituted 'soft rap'. But we weren't left waiting for the main man for long. Excitement was rising and released with immediate adrenaline as the energetic Carner burst on the stage with 'Hate', a fast-paced storm. The crowd was electric and the screams of support were never-ending. Stood in a singular spotlight with his head in his hands, Carner was clearly overwhelmed.
A careful lyricist, he doesn't shy away from voicing issues surrounding race and identity in songs such as 'Georgetown'. The lyrics feature lines from John Agard's poem 'Half-Caste', giving the performance a poetic quality.
Stood
He recognises the importance of being the change you want to see in the world and uses
Poignantly talking to the crowd about his young son and his relationship with his father, his openness transcends just his music. In 'HGU', he speaks transparently about the importance of forgiveness for yourself rather than for the person you are forgiving. This set him free.
His personal connection and authenticity are invaluable as his performances feel like conversing with a friend. I was lucky enough to see him outside after the show, and he spent time talking deeply with his fans. Many told him about the impact his music has had on their lives. He could not have looked more grateful.
Our personal takeaway from the night can be summed up by his phrase "Take these words and go forwards." No matter where you are in life or who you
There are moments elsewhere, however, that let Cracker Island down a little. The gifts brought by their collaborators, from Thundercat’s gloopy basslines to Stevie Nicks’ bewitching vocals, are largely squandered by some odd production choices. Moreover, tracks including ‘The Tired Influencer’ and ‘Baby Queen’ are marred by an irritatingly drum-forward mix, which subjugates the vocals just enough to make it feel as if your eardrums are being flicked by the snare on every two and four.
Highlights include their collaboration with global superstar Bad Bunny Lyric of
Cracker Island is not quite a let down from Gorillaz. There are some genuinely fantastic moments, lyrically and musically, that more than warrant a listen. Nevertheless, there are equally moments that restrict the album from fulfilling its sonic potential, leaving one to wonder whether the innovative well that Gorillaz have drawn from over the past two decades is beginning to run ever so slightly dry.
I can't promise that I'm going to be fine, but I'll throw my best punch every time
THE COURIER Sub-editors: Lucy Bower & Rowan Christina Driver Monday 6th March 2023 Music 25
Lyndsey Sleator & Kirsten Scott
t h e Week:
Frank Turner, Punches
Image credit: Spotify
Personal, honest, and intimate, his performance had us both tearful and joyful for life
in a singular spotlight with his head in his hands, Carner was clearly overwhelmed
Image credit: Loyle Carner on Facebook
Image credit: The 1975 on Facebook

Netflix password sharing: the truth behind the lies Love & Death
 Heather Adams
Roseanna Leconte
Heather Adams
Roseanna Leconte
HBO Max has just dropped the teaser trailer for their upcoming limited series, Love & Death, which is set to be released on the streaming site on April 27th.
The forthcoming crime drama follows the life of Candy Montgomery (portrayed by Elizabeth Olsen), a churchgoing housewife from a small town in Texas, who has a seemingly picture-perfect life with her husband and children. However, feeling unfulfilled in her personal life, Candy decides to engage in an extramarital affair with Allan Gore (Jesse Plemons), the husband of her fellow churchgoer friend, which has rather bloody consequences.

The series is based on a true story and also features Lily Rabe and Patrick Fugit as the spouses of Olsen and Plemons. And, if the stars of this highly anticipated series weren’t enough to get viewers excited, the show was written and executive produced by David E. Kelley, who is responsible for several other recent HBO series’, such as Big Little Lies and The Undoing
The streaming giant originally trialled the anti-password sharing tactic in Latin America, and, since the 8th of February, it has now been implemented in Canada, New Zealand, Portugal, and Spain.
The new system involves members setting up a ‘primary location’ for their account - anyone on that account that does not live in this location has the option to transfer their profile data to a new account. Netflix have said this won’t affect people using their account when travelling on holiday, though it is not currently clear how this is going to work.
In addition, there is an option to pay an extra monthly fee to use a Netflix account from a different household. In a cost of living crisis, this is quite a bold move considering how much their prices have gone up over the years already.
Netflix insists that the issue of password-sharing affecting their revenue is impacting their ‘ability to invest in great new TV and films’. However, in
recent years there have been several fan-favourite shows cancelled after just one season despite backlash. It’s therefore starting to become difficult to believe that Netflix truly cares about its paying members as much as they claim to.
There are many reasons why people use their Netflix accounts outside of their home, such as using handheld devices to watch their favourite shows whilst out and about. Surely Netflix should want to encourage this, but introducing a location restriction is going to cause unnecessary hassle that will simply put people off. Moreover, the move threatens university students who are constantly travelling between their home and place of study - why would Netflix want to alienate such a significant part of their audience?
It seems that Netflix has really changed its tune, as it used to embrace password sharing as a marketing tactic, tweeting in March 2017: ‘Love is sharing a password’.


The new system, which has inevitably received a lot of backlash, is going to be rolled out more broadly by the end of this month, which is most likely going to include the UK. With so much competition nowadays, I have a feeling that this change could be detrimental to Netflix, as they will lose many subscribers to platforms like Disney+. No one is happy about it, so I’m sure people will find loopholes…
Physical 100: the search to find the perfect body
Castor Chan - TV sub-editor
making the athletes sweat.
However, many people watching the trailer may have felt it looked oddly familiar and that is because this is not the first dramatized retelling of the Montgomery/Gore story. In 2022, Jessica Biel portrayed Candy in a Hulu limited series, eponymously titled Candy, and, despite flying under the radar, received many positive reviews, including a four-star review from the Guardian, which described Biel’s performance as ‘phenomenal’. Therefore, it would seem that Olsen and this series have a lot to live up to.

But, if the recent pairings of HBO and Kelley are anything to go by, it should be safe to assume that this series will not disappoint. Despite only being a minute and a half in length, the short trailer is exciting and gripping and Olsen’s intense performance appears to just be a teaser for what remains in store.
If you’ve had Netflix in the past month, it’s likely you’ll at least have seen the thumbnail for Physical 100 across your home screen. With a range of impressive physiques, theatrical challenges, and unexpectedly wholesome friendships, this nowviral show was an enjoyable watch despite some pacing issues. If you haven’t already, I’d at least give it a shot.
Called “The best Netflix show of the year so far” by Forbes (admittedly in February) and having become the top non-English show on Netflix, Physical 100 has proved to be another Korean hit. The pilot starts with contestants literally sizing
Physical 100’s whole premise is to find “the most perfect physique, regardless of gender, age, or race”. With a balance of agility, strength, endurance, and speed tests, the unpredictability of the next challenge evened out any advantages a little bit and ensured that it wasn’t immediately an all-male game. There were some biases when it came to strategy - Jang Eun-sil’s team, made up of more women than the others, pulled off a surprise victory against a ‘stronger’ team who chose them hoping for an easy win. Her team, combined with another that had an injured player, ended up losing the next round in a strength competition.


There is also a shocking amount of editing, not exactly in the way this implies. There will be challenges where clips of contestant interviews are put in, and given that those usually revolve around wanting to win, it’s a little bit exhausting to keep hearing. Another type of editing centres
Going back to the Atlas challenge - the last two standing actually lasted just over two hours, but was condensed into a few minutes. It’s inspiring how much mental strength everyone on the show has, and they give it their all every time.
Beyond their physical and mental qualities, the athletes have a ton of respect for each other, and it makes the show quite wholesome. In each competition, they root for each other regardless of prior teams, one example being Ma Sun-ho visibly tiring out during a challenge. The watching contestants start chanting, “two, three!” in a bid to encourage him to keep pushing. When they stop, Ma looks up at the viewing platform and asks “Do that again for
I’ll admit that I got attached to different contestants, Jang min, MMA fighter Choo Sung-hoon, etc And honestly, a quick look on Twitter will tell you the same story. As impressive as those athletes are, I think it’s this human aspect that had me going back to the show. If you want something as Squid Game but with a little less death, is one to put

THE COURIER Sub-editors: Castor Chan, Olivia Crowley & Imogen Smillie Monday 6th March 2023 TV 27
Sharing is caring, but not according to Netflix...
Olsen, and this series, have a lot to live up to
Olsen is back with a vengence in this shocking retelling, proving there's a thin line between love and death!
Image credit: Twitter @netflix, Pixabay
Image credit: Twitter @frlizzieolsen
How a Korean fitness reality competition shot to second most popular on Netflix
Image credit: Jang Eun-sil Twiiter (@ueberdenwolkenn), Wresting Twiiter (@BenjyBox)
The athletes have a ton of respect for each other, and it makes the show quite wholesome
Review: Marcel the Shell with Shoes On: a life-affirming classic in the making
Ned Carter-Owen
lived in the home split up and the shells were mistakenly packed away with the socks.
Marcel, voiced by Jenny Slate, is a shell with one eye and two shoes living in an Airbnb alongside his grandmother Connie, voiced by Isabella Rossellini.


The two of them have been separated from their original community, made up of over 20 other shells, He cries "but what if everything changes?"
The creator of this documentary, Dean, played by director Dean Fleischer Camp, moves into the house after a divorce and begins interviewing Marcel and Connie, uploading videos to YouTube which end up going viral. Interestingly, Jenny Slate and Dean Fleischer Camp used to be married themselves (Death, Sex & Money 4/01/23). After divorcing, the couple continued to work on the project together in good humour, offering then, an explanation as to why change and the anxiety that comes with it, is so tangible throughout.
around in Dean’s car, Marcel is amazed by for its audience to embrace change in pursuit of their goals. In a scene where Marcel suddenly feels daunted by the prospect of new experiences, he cries “but what if everything changes?” Connie Whilst it is easy to see time moving on as just months and years, it is important not to forget “the changes in the trees” or overlook the “buds that have closed and bloomed again”. If you’re feeling somewhat disconnected from the world around you, this film is a
Both dealing with a kind of separation, Marcel and Dean navigate their new internet fame as they continue to search for the other shells. What ensues is an emotional rollercoaster of delight as we see Marcel’s adorable ingenuity, like his use of honey to walk up walls, but also Connie’s deteriorating physical health. When I went to watch this film in what seemed to be a distinctly child-free theatre, there were two other men on my row – we all shed tears at least once.
Aside from the obvious visual charm of this movie, where it shine lies within the childlike wonder of Marcel and the wisdom of Connie. Seemingly mundane things are noticed and revered by the young shell. Driving
The final girl trope: misogynistic or
 Olivia Crowley - TV Sub-Editor
Olivia Crowley - TV Sub-Editor
The iconic horror trope has long been tied to ideas of sexuality. Has this trope evolved into a feminist trope?
The trope of the ‘final girl’ is a long, overdone symbol of the slasher subgenre of horror. Whilst it outwardly seems like an empowering win for women, it falls victim to the subversion of sexuality in order to survive. It’s not necessarily the problem of the ‘final girl’ character in itself, but rather the sexuality and stupidity alongside it. Typical male stereotypes that are portrayed just can’t live up to this position due to their seemingly clouded masculinity that is far too important to them; they have an urge to die for women, and more importantly for the chance to have sex.
one is left (likely the ‘final girl’). The role of the surviving girl carries with it its own stereotypes; as Laurie in Halloween (1978) embodies, the ‘final girl’ undergoes a level of desexualisation, never partaking in drinking, smoking or sexual activities, unlike everyone that eventually dies. The role is, therefore, granted to the girl who remains the most moral and androgynous.
Scream catalysed this change, introducing audiences to a smart and self aware group of teenagers
to implode; this ends up happening as a result of their awareness and their unwillingness to sacrifice themselves.
The subgenre of the slasher is the most profitable within the horror world; perhaps the simplicity of sex, violence, and blatant stupidity provides an easy watch for people to enjoy. In order to achieve this, there are a set of rules that every classic slasher flick should follow, as Scream (1996) would have us suggest. There should be a deranged (often masked), weapon wielding psycho, chasing a group of morally like-minded teenagers, killing them off one by one. This happens constantly until only
Whilst the ‘golden age’ of slashers existed throughout 1970-1990, the campy, sexist final girl trope soon changed within an ever-changing political and cultural climate, as those who survived switched from a state of vulnerability to a strong and resourceful match from the violent character she faces. Arguably Scream catalysed this change, introducing audiences to a smart and self aware group of teenagers, with many characters such as Randy, using the classic slasher rules in order to eventually survive the killer. Sydney embodies the role of the ‘final girl’, despite having sex, and partaking in partying, something that turned the genre on its head. Despite this, Sydney is targeted as a result of her mother’s sexual promiscuity that led to her eventual downfall.

Many films have since focused on this change, switching how we look at the slasher genre from an audience perspective. Take Cabin in the Woods (2012), a flick that mocks the categorical tropes of slashers, with each character embodying an extremely stereotypical trait (including the athlete, the virgin and the fool). In this world, if the teens don’t die in their specified order, then the world is set
(2009) also rewrites the classic subgenre, as the role of Jennifer embodies the villain but also the ‘final girl’ of sorts, becoming an instant feminist cult classic as she chooses to kill only men regardless of their sexual status. She partially survives the film due to her status as someone who doesn’t have her virginity, completely doing a 180 in terms of the slasher rules.
Despite stereotypical nuances, most of the fun of a slasher film is the fact that almost everyone dies. It is almost comforting to know it isn’t happening to you; but is one woman’s survival worth the loss of so many others? I don’t think so.
But as the role of the ‘final girl’
develops from morally focused luck, to the sheer will to live, it is interesting to see how one goes about her position as someone who is almost guaranteed a gruesome death, giving us a main character to ultimately root for against the monsters that are put before

THE COURIER Sub-editors: Rachel Carron, Mitchell Hall & Jessica McKeown Monday 6th March 2023 Film 29
Image credit: Twitter @FinalDude78
Perhaps the simplicity of sex, violence and blatant stupidity provides an easy watch
Connie simply replies "It will."
A beautiful depiction of life in all its unexpectedness.
empowering?
Image credit: Twitter @universaluk
Image credit: Twitter @marcelthemovie
Review: What's love got to do with it?
Anna Nix
Lily James' latest role takes a unique look at what it means to be a woman in love.
What’s love got to do with it? is a beautiful film about love and all the struggles that come along with it.
The film follows a documentary film maker Zoe, played by Lily James, who decides to shoot a document about her childhood best friend Kaz, played by Shazad Latif, who chooses to find a wife through arranged marriage – or as he calls it ‘assisted marriage’.

Zoe is a strong heroine that is more ‘focused on glass ceilings rather than glass slippers,’ as Lily James describes her own character in the film. She is independent yet she is still vulnerable and is sometimes herself trapped in the whirlpool of love. She tells her own love story (and its mishaps) through comparison to nearly every fairy-tale princess out there, always tailoring it to suit her own circumstance.
Zoe is a strong heroine that is more focused on glass ceilings than glass slippers
As Zoe makes her documentary in the film, the film itself has some attributes of a documentary. In that every conversation the characters have seems very real, balanced and natural, oftentimes filled with humoured banter. This way, it makes for a
joyful ride through the whole of the film. The plot of the film seems to be rolling out slow, as Zoe follows Kaz’s journey to find his wife, yet the audience could hardly be bored. This is most likely attributed to the execution of the cinematography. The pace between individual shots is very quick as the camera switches from one character to another in separate scenes, and can seem even too hasty at times, but it makes for an engaging outcome.
I also thoroughly enjoyed the film’s outlook on love. Walking into the cinema, I thought 'I am in for a classic romance movie,' but I was quickly surprised to find more than just that. The film’s main focus is love, yes, however the tale of love was told through many spectrums. Other than romantic love, the love of family and friends was heavily present through the entirety of the film. And the bond of love in the end overcame hardships like time, alienation, religion, race, mistakes and differences of opinion.
The portrayal of each characters was also brilliantly done. Lily James was a wonder to watch, although I might be slightly biased, as I am a fan of hers. Shazad Latif delivered a great performance
To put it simply, I have fully enjoyed this movie and if I were to sum it up in three words, it would be these: refreshing, real

International Women's Day 2023: female directors worth celebrating
Sarah Tunstall - Arts Sub-Editor
13 years since the first female winner of best director at the Oscars, it remains as important as ever to celebrate women behind the camera.
When I think about female directors to look out for, I first think of the slight disappointment that there is in the fact that we must explicitly look out for lists of female directors to keep an eye out for. Given that, there is no doubt I have a large mental list of all the female directors that have taken my breath away in their depiction of film.

demonic sex symbol for 90 minutes. But given its actual repertoire, the movie has since been recognised as so much more.
Kusama’s work has since been recognised as the iconic feminist film that it is and has become a cultural basis for the new age horror. Its explosive with feminism and sapphic homoerotic scenes, denouncing any idea of its gaze being male-orientated, and rejecting the modern teen girl drama expectation.
The first name that comes to mind is Karyn Kusama, an acclaimed name of the early 2000s with her release of Jennifer’s Body which has admittedly become popularised in later years rather than as it came out. Jennifer’s Body was coined as the typical teen drama. The initial critical response deemed it a failure as it was marketed towards teenage boys; Megan Fox as a

Another name that has since exploded in the cinematic universe is, Céline Sciamma, director of Portrait of a Lady on Fire. This film… I cannot even come to words in explaining how its directorial decisions had me floored at the tv. The one thing that caught my eye was the expression of the female gaze in the film.
Though it’s evidently suggested, there are no explicit scenes in the film, because Sciamma has made the idea of it completely futile. Instead, there is this burning chemistry elsewhere, the notice of female body hair, the gaze they share across the fire as Héloïse’s dress is caught by the flame has more intensity than any sex scene could provide. Sciamma really removes this sexualisation of the sapphic body and brings focus to the intimacy that exists between two women. A thoroughly exceptional director. Having said all this, I’ll give you a short list of other female directors that have taken, and are due to take, the cinematic atmosphere by force. Greta Gerwig, director of films such as Little Women (2019) Ladybird (2017) is due to release her film, Barbie (2023) later this year. Often forgotten, The Wachowski sisters, who directed The Matrix films. Sofia Coppola, director of Lost in Translation. Amy Heckerling, director of the highly acclaimed film, Clueless. And, though not the director, Diablo Cody who was the screenwriter for both Juno (one of my all-time favourite films) and Jennifer’s Body
Image credit: Twitter @paigenkiser
5 Monday 6th March 2023 THE COURIER Film 28 Sub-editors: Rachel Carron, Mitchell Hall & Jessica McKeown
Image credit: Twitter-@Working_Title
[Jennifer's Body] is explosive with feminism and sapphic homoerotic scenes
Books, Kindles, or Audiobooks?



ave you ever buried your head in a book and taken a deep smell from it? I have, and I love the smell of books; it feels like I am going to be sucked into the world of Inkheart! As technology has improved, there are more options for us to read. Kindle
and audiobooks are products from recent generations, and they are brilliant tools for people to read. But when it comes to it, what would you choose?
HBooks are one of the greatest human creations in history. I think there are still a great number of people who prefer physical books. The feeling of turning pages is unbeatable. Moreover, reading physical books lends itself to easier concentration and immersion in the world of stories, without being bothered by notifications or pop-up advertisements. Taking books with you when you are out, reading them in a café or on transportation, is an enjoyable lifestyle. Kindles are a handy tool for reading. Using a kindle can save us time to visit a brick-and-mortar bookshop, and with a Kindle, we don’t need to carry heavy books. Moreover, there are uncountable e-books on the Internet we
can download to our devices to read. For a student, e-books are a lifesaver for those of us who have endless reading lists. What about audiobooks? Compared to books and e-books, audiobooks are a tool that allow people to listen to books and do other things at the same time. They create an immersive experience when we put on our headphones, just you and your story. However, audiobooks are not easy for people to take notes from immediately, and we can easily get lost while we are focusing on reality. To find which way of reading suits you, you need to know your own reading habits and realistic limitations. For me, physical books will always be the best way to read. I love to appreciate the beautiful book covers and buy them for my collections, especially the ones with the hardcovers. I get a little moment of happiness when I hold them and feel the weight.
However, no matter which way you choose to consume this medium, we should be happy that technology has advanced so that more people can read in their own way.
Roald Dahl censoring controversy
 Emma Hunter
Emma Hunter
If you look with a calm gaze past the furore that has exploded around publishing house Puffin’s decision to reword and make additions to parts of Roald Dahl’s books, you can see that its effects and intentions have been blown way out of proportion. They are at worst simply benign, and at best actually beneficial to readers.
Despite the fervent opinions of critics, authorial censorship is the last thing the revisions accomplish. Nothing is detracted from the main storylines, and the glorious, imaginative worlds that Dahl created and drew us all in as children remain as rich and sometimes terrifying as ever. In fact, the edits make this richness and irreverence accessible to readers who would otherwise be turned away. Imagine, at primary school age, already feeling uncomfortable with your body image then finding out Augustus Gloop is made to seem more villainous for being “fat”. Or being a girl feeling intimidated by the boys in your physics class only to hear that a witch posing as a woman is probably a “cashier in a supermarket or typing letters for a businessman”.
to today. Their existence reinforces and subtly ingrains negative stereotypes that are clearly present in society today, particularly among older readers who were first exposed years ago, but also in younger generations. I’ve certainly had to work on myself to break down some of the biases learned at a young age, likely perpetuated by the books I read. Publishers should use their positions of cultural power and agency to help break down these harmful associations. Outdated views are for museums and history books, to prevent these views from being normalised.
A final thing to remember is that language changes are a standard part of editorial procedure. Heck, I’m sure The Courier’s wonderful editorial team will switch up some of what I’m writing now to make it suit its target audience better. Even when it was first published, Dahl’s content had to be changed due to objectionable aspects, such as turning Oompa Loompas from human pygmies from an African jungle (undeniably
phrasing apparently equalling the fictitious villainy of the Witches and the Twits. Puffin have taken it upon themselves to save their readers from the wicked wording of these books, with ‘fat’, ‘black’ and ‘white’ among the words struck from their new classics collection - a real knight in shining armour moment. Sarcasm aside, although Puffin's intentions may be pure, the misguided act of shielding their little readers from the ugliness of the real world hiding in the political implications of words like ‘fat’ only reveals far more malicious implications. Whilst only minor and almost insignificant, those changes compromise the author's integrity and the freedom to make those choices. If free speech is being jeopardised, then at what point does Puffin's censorship become less about protecting their readers and more about control?
Puffin, despite their noble notions of protection, are only imposing their own modern sense of right and wrong onto books that are over 40 years old. Whilst Roald Dahl may not have held the most progressive beliefs (Oompa Loompas? Only
at all really.
Censorship must always be treated with horror. To deny access to literature in its intended form is to deny children their rights to free thought. And if the books really offend you that much, simply pick another one.
It is still a free world despite Puffin's efforts, so lets keep Roald Dahl free, and those offended by him can choose to remain free of Roald Dahl.
Puffin aimed to promote inclusion and diversity in children’s literature by publishing these versions, which it has. But beneath this, publishing houses are smart, and know their market well – it is not unforeseeable that libraries and schools would think twice about exposing children to Dahl’s books due to their offensive content anyway. They didn’t aim to censor, simply to move with the times – the shift is a cultural one. Would it be better for the books to be more sensitive, or not to be read at all?
And it is undeniable that parts of Dahl’s books are offensive. Their target audience are young and impressionable readers who risk not being able to recognise that the offensive nature stems from the author coming from a culture with completely different values
THE COURIER Arts Sub-editors: Louise Cusine, Martha Probert & Sarah Tunstall 30
Image credit: Flickr
Two of our writers put forward their positions on the recent censorship debates concerning the works of Roald Dahl
To deny access to literature in its intended form is to deny children their rights to free thought
Language changes are a standard part of editorial procedure
Nothing is detracted from the main storylines, and the glorious, imaginative worlds that Dahl created
I-FEN YANG
Image credit: Pixabay
Monday 6th March 2023
Sub-editors: Louise Cusine, Martha Probert & Sarah Tunstall
Museums and Colonialism: What is the best solution?
Zahra Hanif - Lifestyle Sub-Editor
How and why museums in the UK should ensure they address their colonial histories
The only way that museums can truly serve justice to their colonial history is by performing reparations, and returning their stolen artefacts. While many museums have opted for simply inviting in the marginalised communities that they have stolen from as a means of providing context for the object’s place in their history and culture, this is nothing more than continued exploitation. It is a performative display that ostensibly takes accountability, but still clings on to the looted goods.
home by Zahra Hanif

Stolen artefacts have no place in a country that didn’t create them - there is the loss of cultural heritage, that can only honestly be regained upon
repatriation. While an acknowledgement of the object having been displaced is a step forward, it still isn’t truly ethical. It is a gesture that lacks commitment, an attempt to simply shrug off colonial guilt in an unchallenging way. There is the argument that these objects, as part of exhibitions, home four walls or countless veins a heart that's pulsating out of its socket or a door with a key and a lock on it is it about that leak in the ceiling or that boundless silence that's letting you know you could never be alone in the feeling forgive me, i'm eerily definitive in spite of it all but my god, what else do i do when the loft's echo has your pitch the lights flicker to your breathing pace and behind my eyelids lives your face

can serve to inform a country of other cultures, but again, this isn’t a good enough excuse. Spreading awareness of other cultures is obviously helpful, but this can easily be done in a more respectful way, a way that doesn’t involve the forceful removal and displacement of pieces of ancient history.
New Banksy leads to freezer palava The evolution of theatre etiquette
Martha Probert - Arts Sub-Editor
The piece, which includes a separate chest freezer, appeared in Kent just before Valentine's Day
The most recent confirmed artwork from anonymous street artist Banksy has appeared in the seaside town of Margate. The piece, entitled 'Valentine's Day Mascara', appeared two days before Valentine's Day, on which date it was confirmed to be a Banksy.
Commenting on domestic violence and misogyny, it depicts a 1950s housewife with a black eye and chipped tooth, and the legs of her husband, whom she has pushed into a chest freezer.
The piece includes an actual chest freezer, placed against the wall on which the work was painted, and which became a source of considerable chaos. On Valentine's Day, the freezer was removed by Thanet District Council, but was reinstated on the following day. However, later that same day, it was taken away once again, this time by the Red Eight Gallery. Three days later, on February 17th, the artwork's eventual home was revealed to be Dreamland, a popular tourist attraction in Margate. In addition, once a buyer for the piece is found, a six-figure sum will be donated to the Oasis Domestic Abuse Service (also situated in Margate).
In a poll conducted by KentLive, 81% of those surveyed responded YES when asked, "Should Banksy artwork just be left alone?". The freezer

 Jenica Davis - Lifestyle Sub-Editor
Jenica Davis - Lifestyle Sub-Editor

How much has theatre etiquette evolved over the years?
When you buy a theatre ticket, you sign an unspoken agreement: you have agreed to take on the role as an audience member, a role that comes with a set of rules. Like the actors on stage, everyone needs to play their part.
What is theatre etiquette?
Theatre etiquette is the code of behaviour that all audience members are expected to follow in order for the audience and performers to have the best experience possible. A lot of time, money, and effort goes into putting on an enjoyable theatre show, therefore it is an event that is deserving of respect. Whilst everyone will have a different idea of what ‘correct’ theatre etiquette is, the fundamental rules to follow are arrive on time or (ideally) slightly early; go to the toilet before the show starts and during the interval if you need to; turn your phone off and put it away; do not speak during the show; do not put your feet on seats (keep to yourself); avoid eating smelly and noisy snacks; refrain from talking about someone’s performance until you have left the theatre; and be polite and respectful (to both the actors and other fans) if you are waiting at the stage door.
These basic, behavioural rules for audiences seem very straightforward, and are arguably common sense. Yet, theatre etiquette has seemed to become lost amongst crowds in recent years.
How have theatre audiences and expectations changed over time?
Theatre audiences in ancient Greek times were extremely rowdy and vocal; many uproars would occur if audience members were upset with a certain aspect of the show. Lively theatre crowds continued into the Renaissance era, with crowds heavily drinking and eating, engaging in romantic
trysts, and notoriously pick-pocketing, all whilst Shakespeare’s newest play was being performed. Disruptive audience behaviour saw some reform in the eighteenth century when the audience started to be separated from the stage, but it wasn’t until the nineteenth century that this structural separation was properly imposed. Soaring in popularity, the use of the proscenium arch and limelight divided audience members from the performers; the audience was in the shadows and the performers were illuminated. This enabled the behavioural policing of theatre crowds and, by the end of the century, a social ‘contract’ in theatres was enforced – which we now know as theatre etiquette.
However, the expectations that follow theatregoing today have changed quite drastically. People don’t get dressed up for the theatre anymore, unlike back when it was seen as an ‘event.’ This more casual atmosphere has subsequently led to theatre etiquette becoming forgotten, with crowds dressing down their manners too. From late arrivals to loud wrappers, there are a lot of rising issues amongst theatre audiences, however the most predominant issue in the last decade appears to be phones; a lot of actors have reportedly stopped midperformance to call out certain audience members or even confiscate their phones. The crowds found at the stage door after the show have also become very untamed, being rude and aggressive to those around them so they can snatch the chance to speak to their favourite actor.
Whilst theatre etiquette needs to be re-instilled into today’s audiences, theatre still needs to be accessible for everyone. Certain etiquette rules are argued as discriminatory, not taking disabled people into consideration, such as people with tourettes. Therefore, when reinforcing theatre etiquette, it’s vital not to enforce abliest behavioural norms, because theatre is an experience that should be open to everyone.
Ultimately, all that theatre etiquette boils down to is respect. Whether you are going to see a beloved show at the West End or your local theatre’s Christmas pantomime, theatre etiquette should always be remembered.
THE COURIER
Arts 31
Image credit: PxHere
Attempts to address colonialism often result in nothing more than continued exploitation
Image credit: @DreamlandMarg on Twitter
Image credit: Flikr
Monday 6th March 2023
Across
1. Formula 1 team with Carlos Sainz (7)
4. Capital city of Vietnam (5)
8. What is the first name of Dan Aykroyd’s character in Ghost Busters (3)
9. What day is pancake day (9)
11. Scale measuring acidity and basicity of a solution (2)
12. When a speaker refers to themselves and one or more others (2)
14. Uncertain (5)
15. Longest river in the UK (6)
18. Car recovery company (2)
19. A classical poem originally meant to be sung (3)
21. An intense armed conflict between two or more states (3)
24. Amethyst Amelia Kelly (4,6)
25. 1982 sci-fi film directed by
Word Ladders
Start at the top of the ladder, and change one letter each time to form a new word. By doing this, you will be able to get to the word at the end of the ladder.


Stephan Spielberg (2)
28. Peer to peer, Token ring and Token bus are all types of ___ (3)
29. English romantic poet, born January 1788 (5)
33. What is the largest beer manufacturer in Europe (8)
34. Cinema company (3)
Down
1. Focus, Fiesta, and Ranger (4)
2. Oldest premier league manager in history first name (3)
3. Animated TV series airing from 1996-2022 about an aardvark (6)
5. A negative answer (3)
6. A whole number without fractions (7)
7. A land mass surrounded by water (6)
10. The Latin word for water (4)
13. Chemical symbol for Helium (2)
15. Team that has won the Europa league the most times (7)
16. American actor starring in the film Dodgeball (6)
17. Company that makes FIFA (2)
20. Name that means the living one in Hebrew (3)

22. A type of beer (3)
23. Lock manufacturer (4)
26. An accent placed above an n in Spanish or a symbol that means approximately in maths (5)
27. Expressing the situation of being enclosed by something else, we’re locked __ (2)
30. Ginger one from Harry Potter (3)
31. Hello (2)
32. Phone company (1,1)
Joke of the Week:
George Bell - NSR Production Manager and
Courier Jester

THE COURIER Puzzles Sub-editors: Rhys Mason & Leo McManus-Andrea 32 Crossword Monday 6th March 2023
The past, the present and the future all walked into a bar. It was tense.
Nonogram



Puzzles 33
Instructions
Colour in the cells in the grid according to the numbers on the sides of the grid to reveal a picture. The individual numbers in each row/ column are separated by spaces of 1 or more squares.
Notes
Issue 1440 Answers
THE COURIER Sub-editors: Rhys Mason & Leo McManus-Andrea Monday 6th March 2023
2 1 1 3 1 2 2 1 1 1 1 1 3 1 2 2 1 3 1 2 4 2 8 5 3 1 2 1 2 2 1 2 1 5 5 4 8 3 5 1 10 2 2 2 1 2 2 2 2 1 2 2 2 10 1 5 3 3 5 3 1 2 1 1 1 3 2 2 3 1 1 1 2 1 3 5 3 3 9 2 3 2 3 2 1 3 2 16 4 2 4 5 1 1 5 5 3 3 5 4 1 1 4 3 2 3 3 2 3 2 2 2 2 2 6 2 5 4 5 1 2 2 1 3 8 3 3 1 4 1 3 9 9 4 2 3 5 5 9 6 6 2 3 1 4 6 13 4 1 2 7 4 1 1 5 4 2 1 1 1 1 1 1 5 5 4 4 2 2 1 2 2 4 5 7 2 1 3 2 3 3 3 3 3 3 3 3 3 3 2 3 4 7 10 11 2 11 4 9 6 2 1 6 3 2 4 6 2 1 3 4 2 4 4 10 1 10 5 6 14 1 1 14 1 12 10
A PRIZE! Upload your puzzle solutions to Instagram and tag @thecourieronline to enter the prize draw! C A P Y B A R A E P E E A R E A A O R R I Y M C A I S E O U L A S I L K S P L L S S T K I L L O N E H O L L A N D A N O Y O A P E U V F O C A C C I A B T L K L L B U N O S H A F T U A R Y E G G A G A R I N A D A M S
WIN
Wu Yibing makes history at Open
Carly Horne - Head of Culture
Wu Yibing has become the highest-ranked Chinese player in the history of ATP Rankings, following his victory at the 2023 Dallas Open.
Yibing defeated the USA's John Isner, currently ranked No. 37.
The 23 year-old made his ATP debut at the 2017 Chengdu Open as a wildcard, but has more than proven himself in subsequent tournaments. Throughout the Dallas Open, Yibing went from strength to strength, winning the final 6–7(4–7), 7–6(7–3), 7–6(14–12).
"It's not only about winning the title, I think it's more about me personally making history and also for the country," Yibing said, speaking in the aftermath of his win at Dallas.
Wu Yibing has become the highestranked Chinese player in the history of ATP Rankings, following his victory at the 2023 Dallas Open. Yibing defeated the USA's John Isner, currently ranked No. 37.
The 23 year-old made his ATP debut at the 2017 Chengdu Open as a wildcard, but has more than proven himself in subsequent tournaments. Throughout
Quins in crisis: Harlequins lose five matches in a row
half.
Sarah Castledine
the Dallas Open, Yibing went from strength to strength, winning the final 6–7(4–7), 7–6(7–3), 7–6(14–12).
"It's not only about winning the title, I think it's more about me personally making history and also for the country," Yibing said, speaking in the aftermath of his win at Dallas.
"It's more about me personally making history"
Following a number of injuries, Yibing found himself tied for No. 1869 in world rankings only last year.
Wu's meteoric rise in the ATP rankings has been nothing short of remarkable. In just one week, he climbed an impressive 39 spots from his previous ranking of 97th to an impressive 58th position. This remarkable accomplishment has catapulted him to the position of the highest-ranked Chinese tennis player in history, though it seems this is just the beginning of his journey.
He has also made history as the first Chinese player in the Open Era to win an ATP singles title, as well as the first Chinese player to compete in an ATP final.
Wu has already established himself a serious contender in the sport, but defeating first-rate players such as Isner, Adrian Mannarino and Taylor Fritz at only 23 years old makes him one-towatch in the coming months.
What is wrong at the Stoop?
Harlequins rugby team are not heading up the Gallagher Premiership table anytime soon, after a shocking 5 game losing streak. The south west London team are usually a strong team to face, with five of their players being called for Steve Bothwick’s England squad who are facing Wales on Saturday. The team most recently faced Gloucester, who are fourth on the table and lost to a pitying 28-26.
Hopefully the team can bring back their famous game play before playing against one of their biggest rivals, Saracens, at the end of March. As they are currently at the top of the table with 57 points compared to Harlequins 34, Quins need to change their game plan quickly if they want to progress further.
The team is most famous for providing many players for the England team and for the Lions Tours. Some of their current most famous faces are: Joe Marchant, who primarily plays centre for Harlequins, Alex Dombrandt, primarily a fly half, and Marcus Smith, who has become a regular England player following Owen Farrell as a fly


Formula One pre-season testing gets underway on Bahrain track
Lara Kelland
An update on the 2023 F1 testing, after liveries are released
Race season is almost back in business as the teams gather back on the grid to shake down their 2023 challengers. Ninety-five days after the final race of 2022, F1 has landed in Bahrain for pre-season testing. With all the new cars unveiled, for three days in February each was plugged with sensors as the teams scrambled to overhaul their weaknesses ahead of 2023’s first race
Red Bull remain the favourites, with Perez and Verstappen both snatching fastest lap times with minimal technical mishaps. But, after their disastrous season last year, Mercedes will be keen to prove they’re still up to championshipwinning pace. At first glance they don’t appear to have made too many drastic changes to their car, opting for the low side-pod design that they’ve favoured the past few years. However, the crippling porpoising (which was so bad it left Lewis Hamilton in visible pain) seems to have subsided, with George Russell commenting that ‘the bouncing is definitely more under control’ and that the car feels ‘nicer to drive’. That being said, Russell was held back on day 2 following a hydraulics failure – a serious problem that would usually take a driver out of a race.
As for Ferrari, the problems of the past may not have gone away so soon. They experienced issues with tyre degradation, but also

some aggressive looking porpoising. It’s possible that this bouncing was caused by experiments with ride height, but it still raises questions as to the team’s technical reliability this year. Ferrari also welcomes new team principal Frederic Vasseur, who hopefully should smooth over some of last year’s illogical strategy calls.
Ferrari welcomes new team principle Frederic Vasseur
2023 also sees the addition of three new rookies to the track, as well as some driver changes and Hulkenberg’s return with Hass. Both Aston Martin and William’s look comfortable with their new drivers, with Alonso not far off Verstappen’s pace in his Aston, and William’s running a smooth weekend with newbie Logan Sargeant. Oscar Piastri’s introduction to F1 doesn’t look to be going quite as easily, with his being the only spin of the entire weekend and McLaren suffering a barrage of problems including braking and the dreaded porpoising.


2023 sees three new rookies
But, despite hardships at McLaren, the midfield looks generally strong. And with Mercedes and Ferrari’s gameplans still a mystery, it’s looking like Red Bull have a competitive grid on their tail this year.
Harlequins will move up the board if they win their next game as they are currently tied in points with Exeter Chiefs, who they are playing next on 4th March. This game will played on home turf for Harlequins, at Twickenham Stadium, so the pressure will be on to prove to fans their shot at the Gallagher Cup isn’t over. To add any more pressure to the players, their 2022/23 seasonal hospitality memberships has sold out, selling for at least £320, meaning fans want to get their moneys worth!
Imagecredit:Twitter (@Harlequins)
Lance Stroll injured in bicycle accident

Zahra Hanif -Lifestyle
sub-editor
Aston Martin driver Lance Stroll has missed all of preseason testing and may miss the season opener in Bahrain following a “minor accident” in training. While little is known of the circumstances surrounding his injury, with Aston Martin declaring that these matters are “private,” it is widely speculated that he won’t be able to compete in the race on March 5. He has already been forced to sit out of the pre-season testing, sparking rumours about the severity of his condition and whether or not he’ll be able to drive in time.
It is reported that the CanadianBelgian driver is being routinely monitored for recovery, and that he has visited a number of specialists in the hopes that he may be able to compete. However, there has also been discussion of potential replacements to take his spot in the tournament, such as Felipe Drugovich, who already replaced Stroll during testing, or Sebastian Vettel, who’s rumoured to have been in contact with Aston Martin regarding being Stroll’s substitute. No definite decision has been made yet, with Mike Krack of Aston Martin telling the media that Stroll competing is still their ideal scenario, their “Plan A”. There is still lots of uncertainty around the whole situation, with no more details of his injury being revealed as a matter of respect towards Stroll, other than that it is a wrist injury that Stroll

obtained while cycling in Spain as part of his training for the GP. There is some hope for him being able to still compete, as Krack did describe his pre-season absence as a simply “precautionary” measure. While the extent of his injuries remains undisclosed, it is difficult to come to any further conclusion regarding whether he’ll be competing or not, we can only wait until the 5th and wish him a speedy recovery.
Update: It has now been confirmed that Stroll will be racing; however, this article was written before this news came to light.
5 Monday 6th March 2023 THE COURIER Sport 34
Sub-editors: Tom Barlow, Arthur Ferridge, Elena Photiadou & Paige Rutter
Image credit: Twitter (@MilGrauDrugo)
Hopefully the team can bring back their famous game play
Image credit: Twitter (@backImage credit: Twitter
Russell was held back on day 2 following a hydraulics failure
(@redbullracing)
“We’ll be back”: Newcastle’s dream cup campaign ends in Wembley tears
Arthur Ferridge - Sport sub-editor
Newcastle United’s fairy tale season failed to receive the happy ending its fans wanted so badly as the Magpies fell 2-0 to Eric Ten Haag’s new-look Manchester United in the Carabao Cup Final. While Newcastle fans will undoubtedly be feeling immeasurable disappointment at the result, the match is a marker of the incredible progress the club has made since PIF’s takeover in 2021 and an undeniable sign of things to come.
Newcastle did not go down without a fight, playing on the front foot for much of the match. They dominated the early stages, attacking relentlessly down both flanks and keeping United pinned back before conceding to a smartly executed set piece just after the half hour mark, finished cooly by Casemiro. To say that this goal came against the run of play would be a significant understatement, as Newcastle had dominated possession and created chances in the lead up.
The second nail in Newcastle’s coffin came just six minutes later as Wout Weghorst played a sweet slide rule pass into the area for Marcus Rashford. Rashford is on the form of his life in 2023, with 25 goals to his name this season, and blasted the ball past replacement Newcastle keeper Loris Karius to double United’s lead. The shot took a significant deflection,

making it hard to pin the blame on Karius, who was forced to stand in for the suspended Nick Pope. Despite the extraordinary circumstances, Karius pulled out an impressive performance, saving eight shots and
providing quick distribution to help bolster the Newcastle attack. Making his first professional start in over two years in a game massive significance, Karius faced unimaginable pressure but delivered a classy performance in spite of the circumstances.


Speaking after the match, Eddie Howe told reporters that “I thought we played well today, there is always fine
Can Kane's goals cover his lack of trophies?
After scoring the eventual winner in a 1-0 victory against reigning champions Manchester City, Harry Kane not only secured his side a much needed three points, but became Tottenham Hotspur’s all-time leading goal scorer while doing so.
He becomes the third player in the Premier League’s history to have 200 goals to his name, joining Alan Shearer (260) and Wayne Rooney (208), the Tottenham striker is certainly on track to become the most prolific goal scorer in the history of English football. While the numbers speak for themselves, it begs the question; can the Englishman’s goalscoring records make up for his trophy-less resume?
Joining Alan Shearer and Wayne Rooney in the 200 club, there remains a distinct difference between the Tottenham number 10 and those that came before him. Along with their goalscoring records, both Shearer and Rooney also experienced tremendous success at the club level. While Kane has been agonisingly close to winning a major trophy with Tottenham, most notably the Premier League in 16/17 and the Champions League in 18/19, the North London side have consistently failed to get over the

line, with Kane yet to lift a trophy with his boyhood club. While the Englishman’s goal scoring numbers can be argued as enough to cement him as a Premier League legend, winning at the highest level is what separates the good from the great. After his attempt to force a move to Manchester City in the summer of 2021 fell through, it seems as though Kane has set his sights on remaining in North London, with several reports of a contract extension surfacing over recent months . Having been 15 years since Tottenham last won a major trophy, the significance on delivering a title to the North London side is unparalleled. With Spurs still in the FA Cup and Champions League this season, time will tell if 2023 is the year Harry Kane lifts his first trophy, cementing his legacy as a true legend of the

Jankto becomes first international player to come out as gay
Rowan Christina Driver - Music sub-editor
Football star Jakub Jankto has come out as gay, making him the first active international player to do so. The Czech Republic midfielder made the announcement in a video uploaded to social media site Twitter on 13 February.
a statement regarding Jankto’s sexuality, revealing it was something he had previously discussed with management, coaches and teammates. “No further comments. No questions. You have our support,” they said. “Nothing else matters.”
Getafe also posted their response to Twitter, declaring their “utmost respect and unconditional support”.
We were disappointed with conceding from a set play but I thought we were in it right until the end.”
“As I sit here now I’ve got no regrets,” he continued. “The thoughts are already going to how we can come back here and win a trophy that we deserve.”
Despite the result, Newcastle United gave their fans a performance they could be proud of. As many as 40,000 Newcastle faithful made the trek to Wembley and created an atmosphere for the ages, with a black and white wall of flags spanning half the stadium. The scenes in Trafalgar Square the night before were just as impressive, as tens of thousands of Geordie’s descended on the nation’s capital and made their voices heard, singing late into the night and swimming in fountains.
Newcastle United’s unprecedented transformation from uninspiring relegation fodder to trophy challengers has been, for lack of a better word, unbelievable, and this cup run is nothing if not a sign of things to come. With one of the most ambitious boards in world football, a top-class manager, and an everimproving squad, Newcastle United will doubtless be sticking around the upper echelons of football for some time.
A-Z SPORTING SPOTLIGHT:
P... is for Pole and Aerial
Chan -TV Sub-editor

He said: “I am homosexual, and I no longer want to hide myself.”

He also expressed his wish to live “without fear, without prejudice, without violence but with love.”
The 27-yearold is currently on loan to Sparta Prague from Spanish side Getafe. The Czech club shared the video on its official twitter account and released
Following the video, Jankto has been met with widespread support. International body FIFA wrote on Twitter, “football is for everyone”. Fans have also been overwhelmingly supportive in the wake of the news. Substituted onto the field in the 69th minute, Jankto was met with cheers from the stands as he played his first game since coming out against Czech team Jablonec, in which he scored a match-stealing goal. Regarding the response, the player claimed it was “a minute [he] will never forget.”
The news comes less than a year after Blackpool forward Jake Daniels became the first active openly gay player in the UK. Jankto joins him as one of a very small number of high-profile openly gay playes in the mens game. Despite this, perhaps in coming out Jankto can inspire more to do the same.
One of the biggest clubs on campus, Newcastle University Pole and Aerial Club (NUPAC) has over 200 members specialising in spins, tricks, and going upside-down.
The huge range of talent in the club also makes it one of the most successful. This past weekend, Newcastle won 2nd Overall University at Edinburgh’s Northern Pole Varsity. With more competitions soon - one hosted here on April 29th! - the club is hoping to repeat its success.

NUPAC also hosts two showcases, offering members the chance to celebrate their hard work. Through performing, the club wants to destigmatise the sport, and demonstrate that pole involves strength, skill, and a close-knit community.
To keep up with events, follow their Instagram @nupac_uk.
THE COURIER
Monday 6th March 2023
35
Sub-editors: Tom Barlow, Arthur Ferridge, Elena Photiadou & Paige Rutter
Sport
Raff Tindale
Image credit: Twitter (@premierleague)
Image credit: Twitter (@Openly) and Wikimedia
Castor
Image credit: Shannon Jamieson
Image credit: Twitter (@NUFC, @StatmanDave, @evfootballtips)
"I am homosexual, and I no longer want to hide myself"
Shut Up & Dance: An interview with the Newcastle Dance Club
 Daisy Harrison - Food and Drink sub-editor
Daisy Harrison - Food and Drink sub-editor
Isat down with NCL Dance Club’s Show Coordinator, Imogen Winfield, to discuss their upcoming show: Shut Up & Dance.



Can you explain the show and the main concept behind it?
The show is a compilation of everything that everyone in Dance Club has been working on all year. We will be performing dances that we’ve been competing with, and by show time, we will have been to five competitions with all levels, from beginners, to advanced. All of the dances that we’ve been competing with will be in the show, and then there’s show dances, which anyone can get involved with. In total, we’re having between 30-35 dances.
Why should people buy tickets?
What can they expect from the show?

The show involves a range of all abilities, and there’s lots of different styles: jazz, ballet, tap, contemporary, street, lyrical, and wildcards (solos/duos/trios). It’s got something for everyone, and if you did ballet as a child, for example, you might want to watch people do the same kind of dances as you used to. Or you might watch something like street, which you don’t know a lot about, and think that it’s really cool.
Where is it being held? Why did you decide on this venue, rather than the same venue as last year, which was the Tyne Opera House?
The show is being held in Northern Stage. We’ve done it here in the past and we always do our competition at Northern Stage. Personally, I like the theatre there; the stage is big, there’s lots of seats, and because of the competitions, we’ve got a good working relationship with them, so I felt that it was a good choice of venue.
Why did you choose the name the show Shut Up & Dance?
Every year, the show name is based on a song. The song we choose will be in the promo video and the show finale, so it all ties together. I feel like Shut Up & Dance is a good song for the show because everyone knows it.
What is your role in the show?
I am the show coordinator. I’ve been involved in booking the venue, as well as liaising with the Northern Stage staff to sort out tickets, and ticket prices. My current project is the running order. We’ve got about 200 people performing, and a lot of people are in up to 11 dances
in the show, so working out the running order has been quite a big task.
Do you think there’s a different atmosphere between the show and competitions, since everyone involved with Dance Club is able to perform in the

There definitely is. With competitions, you want dances to perform as well as they can. This is the case for the show as well, but usually by the time we get to it, people have had lots of practice with performing. With competitions, the atmosphere is very supportive; there’s always lots of Dance Club members in the audience, whereas the vibe for the show is different, as everyone is backstage. The show is a way of showing off to family and friends what we’ve been doing throughout the
Are you going to be involved in any dances? Or are you strictly working behind the scenes?
Yes, I am in 11 dances – whether I’ll regret that on the show night or not is a different question! But it’s not just me on my own. I’ve got people helping me with stage management and everyone in Dance Club is willing to help where they can – I’ve got a good team.
Would you encourage anyone reading this article to get involved next year?


Definitely. I would encourage anyone to come along to watch the show this year, but I think performing on stage, even as a beginner, and having the audience cheering for you is such a good feeling. There’s a big expectation of commitment within Dance Club, so everyone has been rehearsing so much, and the show is a reward for the hard work you put in. Plus, performing on stage, in costume, is so much fun!
Which dances are you looking forward to seeing the most?
I love watching street. It’s not what I’m great at, but the streets dances are always so well put-together and great to watch. I think the audiences really enjoy watching them too. We’ve got a couple of street wildcards, which I think are really cool.
How are you getting the costumes?
We try and re-use the costumes as much as possible, but the teachers get a budget for everyone in their dance. It’s up to the teaches to organise what they would like their dancers to wear, which means there’s lots of variety.
How much are the tickets and where are they available to purchase?
Tickets are available on the Northern Stage website. Adults are £16, students are £10, and under 12s/over 65s are £8.
THE COURIER Sub-editors:
Photiadou &
Rutter Monday 6th March 2023 Sport 36
Tom Barlow, Arthur Ferridge, Elena
Paige
I’ve got people helping me with stage management and everyone is willing to help
Lance Stroll Bicycle accident Wembley defeat for Newcastle United Manchester united steal the glory in Cup final International footballer comes out
will
We
be performing dances that we’ve been competing with
Image credit: Instagram (@ncldanceclub)
First active international player to do so Image credit: Twitter (@Openly) Image credit: Twitter (@evfootballtips) Stroll was in doubt ahead of F1 season staring Image credit: Twitter (@MilGrauDrugo) INSIDE SPORT THIS WEEK BADMINTON M1 V Hull (A) 7-1 M2 V Leeds 2 (H) 7-1 W2 V York St Johns (A) 6-2 BUCS RESULTS
Everyone has been rehearsing so much, and the show is a reward
Image credit: Instagram (@ncldanceclub)
BASKETBALL M2 V Loughboro. 2 (H) 60-76 W2 V Leeds 2 (A) 42-31 FOOTBALL M3 V Hull 4 (A) 5-0 W2 V Leeds Beckett 3 (A) 3-0 HOCKEY M1 V Notts. Trent 1 (H) 5-0 M2 V Leeds 2 (H) 2-4 M3 V Leeds 4 (H) 5-0 W1 V Oxford Brookes 1 (H) loss W3 V Durham 4 (A) 1-3 W4 V Leeds 3 (A) 0-0 W6 V Northumbria 3 (H) 5-1 LACROSSE M1 V Glasgow 1 (H) 16-2 M2 V Durham 3 (H) 3-3 W2 V Leeds Beckett (H) 8-20 W3 V Northumbria 2 (A) 22-8 RUGBY UNION M1 V Bristol 1 (H) 26-10 M3 V Newcastle 4 (H) 62-26 M5 V Northumbria 3 (H) 0-17 POLE AND ARIEL Intermediate 2nd Advanced 3rd Doubles 1st Group 2nd Overall 2nd TENNIS M1 V Nottingham 1 (A) 0-6 RUGBY LEAGUE 2 V Sheffield 1 (A) 16-12 NETBALL 2 V Leeds (H) 59-45 3 V Durham 4 (A) 44-39 4 V York St John 1 (A) 38-47 5 V Sundrland 3 (A) 95-11 SQUASH M2 V Leeds Beckett 1 (H) 2-3 M3 V Durham 4 (H) 3-0 WATERPOLO W2 V Northumbria 1 (A) 7-26
I think the audiences enjoy watching them too













 Mitchell Hall - Film sub editor
Mitchell Hall - Film sub editor


 Madeline Davison
Madeline Davison











 Grace Boyle
Grace Boyle
 Amelie Baker
Amelie Baker

Sohpie McMillan
Sohpie McMillan
 Marina Snyder
Marina Snyder


















 Imogen Smillie - TV Sub-Editor
Imogen Smillie - TV Sub-Editor







 Carly Horne - Head of Culture
Carly Horne - Head of Culture

























 Heather Adams
Roseanna Leconte
Heather Adams
Roseanna Leconte








 Olivia Crowley - TV Sub-Editor
Olivia Crowley - TV Sub-Editor






 Emma Hunter
Emma Hunter






















 Daisy Harrison - Food and Drink sub-editor
Daisy Harrison - Food and Drink sub-editor





